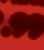

Apolicebossinsists working backwardstotakeoutthose“driving thebusiness”ofcountylinescrimein Shropshireiskey
SinceMay last year,policesay knowndruglinesinthecountyhave beenreducedfrom23toseven.West Mercia Police in Shropshire have beenworkingwithofficersinMer seysideandotherareasofthecoun trytodisruptdrugringsandattack theproblematitssource.





Officersrecentlycrackeddown andclosedtwocountylines,arresting38peopleacrosstheWestMercia forceareaaswellasseizingdrugs worth more than £7,000,weapons includingknivesandmachetesplus £15,000 in cash.Thatwas part of theNationalCrimeAgency’sCounty LinesIntensificationWeek

Duringtheweekofficersvisited 110propertiesand18safeguarding referralsweremadeasaresult










Countylinesisthenamegivento theprocessandoperationofdrugs transportedfrompredominately largerurbanareastosmallertowns, ofteninruralareas,withthe‘line’ referringtothemobilenumberused toorderthedrugs.



SuperintendentStuartBill de scribeditasan“absolutely awful crime”whichtargetsthoseinperil,




andsaidthattacklingtherootcause isanimportantpartoffightingthe issue.“Weknowthatthecriminals attheheartofthemaredetermined totryandselltheirproduct,”hesaid “It’sabusinesstothem.Ittargetsthe mostvulnerableinthecommunity Peoplefromdeprivedbackgrounds, givingthemtheincentivetomake money

“Therealityis,thereisrealharm beingcausedtothembothphysical lyandpsychologically,especiallyin termsofaddictionsthatcanstartup asaresult.It’sanabsolutelyawful crime.”Headded:“Whatisreallyimportantistoworkbackwardtotry andtakeouttheline.Thatwayyou aredealingwiththerealcriminals thataredrivingthebusiness.
“That’snottosaywewon’toffer interventionswithstreetdealers. Butoftenthereisamorecomplex storywiththem.”Anyonewithsuspicionsthatapropertyisbeingused toselldrugs,orthatayoungorvulnerableindividual maybegetting involved with county lines drug dealingcanreportthisonlineunder theTellUsAboutsectionofthepolice websitewestmercia.police.uk
Santaarrivesatthe zoo

Turkey farm supply fears
Turkeysuppliershavespoken ofthe‘nervouswait’andhighcosts ofbattlingtoensuretheydon’tsuccumbtothedevastatingimpactof birdfluintherunuptoChristmas.



Consumershavebeenwarnedof a“big,bigshortage”ofBritishfreerangeturkeysoverthefestiveperiod andhalfofthe free-rangeturkeys produced forChristmas in theUK havealreadybeenkilledinthebird fluepidemic.


Aspokesmanfor one supplier, WrekinTurkeys,saidithasbeena challengingtime.“Wehaveacouple moreweeks to stay safe andthat meansit’sevenmorenerve-wrack ing,”hesaid.
Stolen horse ledtomarket
Policeareinvestigatingafteran elderlyhorsewasstolenfromafield andledthroughabusyGermanmar ket.
Dollar,athoroughbred cross warmblood horse, went missing fromhisfieldinHinkshayonSatur dayafternoon.Policesaidtheyreceived subsequentreports that he hadbeenled throughthe German MarketatTelfordtowncentre,and thattwomenhadtriedtotakehim uptheescalatorintothenearbyAsda store.A19-year-oldmalewaslater arrested on suspicion of theftand criminaldamage.Hehassincebeen released on bail as investigations intotheincidentcontinue

•Fully Welded uPVC Windows, Doors&Conservatories •Internally Glazed with high Security Locks •Composite Doors• Garage Doors •Fascias,Soffits &Guttering •BuildingExtensions WhyChooseA.P.H Windows? • AlluPVCproducts aremade in our ownfactory • Dealdirectwiththe owner • No pressureSalesmen Directly employed craftsmen • Full aftersalesservice • No depositrequired Ourshowroomisfullofideas to help youdecide on thestyle &design of your windows, doors and dreamconservatory Open Mon -Fri 9am-5pmSat 10am 3pm SHOWROOM OPENBY APPOINTMENT Good SupplyOnlyTrade Rates-1 Week Turnaround l direct with the Fu after sales s deposit required COUNTY LINES FIGHTGOESON
Report by Nick Humphreys
Santaandanelf–with BarneyJrthe barnowl–inthe grotto Telford’sExoticZoohaskicked offthefestivitiesforzooguestswith itsownSanta’sGrotto. Thegrotto, whichofficially openedlastSaturday,hasbeengiven thesealofapprovalbyone of thezoo’sspecialresidents–Barney Jr,the barn owl. As well as host ingitsowngrotto,thezoohasalso launchedanew‘BreakfastwithSanta’experienceintheattraction’sJungleCafe. Thefestiveexperiencerunsfrom 9.30amto10.30amonselecteddays Thursday, December 8, 2022 NEWS FEATURE SPORT Bowled over by £10,000 prize Page2 Storeshopping versus online Page 8 Alatepenalty winfor Hornets Back Page www.telfordjournal.co.uk Price when sold £1.20 Theregion’s biggest free weekly newspaper
Charityofferinga caravan
Achildren’scancerchari tyhasraised£70,000tofunda staticcaravantoofferbreaksto localfamilies
TheHarry Johnson Trust hasboughtthecaravanforthe familiesofchildrenbeingcared forbythe Children’s Oncology WardatThePrincessRoyalHos pital,Telford.Itcanalsobeused


bybereavedparents,aswellas stafffromthewardwhoarein needofrespite.
TheTrust helpschildren andteenagersreceiving care fromtheOncologyTeamatThe ShrewsburyandTelfordHospitalNHSTrust(SaTH),providing whatever they need to make thingsthatlittlebiteasier.Itwas



foundedinNovember2014,followingthedeathofseven-yearold HarryJohnson whodied aftera nine-month fight with DoubleHitNon-HodgkinsLymphoma
Harry’sparents, Sallyand Stephen,feltastrongdesireto helpothersgoingthroughsimi larexperiencestotheirs.
Number of children seeking asylum alone is on therise
By Megan Jones
Thenumberofunaccompanied asylum-seekingchildren beinglookedafterinShropshire is up from last year, figures show
Data from theDepartment ofEducation shows31lone asylum-seekingchildrenwere incareinShropshireonMarch 31,upfrom24theyearbefore. Meanwhile,15wereincarein Telford&Wrekin,upfromseven theyearbefore.
TheChildren’sSociety is warningthatlocal authorities, alreadystretched to capacity andstrugglingto findplace mentsforchildrenincare,are leavingyoungpeopleatrisk.
Thefiguresshowthatasy lum-seekingchildrenrepresent asmallfractionofthoseincare intheregion–just0.37percent
Overall,7,411childrenwere beinglookedafter in ShropshireattheendofMarchinthe areawith426placedinfoster care.5,067childrenwerebeing lookedafterinTelford&Wre kin, with 320placedinfoster care
MariekeWidmann,Children’sSocietypolicyandprac tice advisorsaid: “Children arriveherealone,afteratraumaticand dangerousjourney, separatedfromtheir families andlovedones–somemayeven havebeentraffickedtotheUK.”
Jonbowledoverby£10kprize
Abowlingalleyhasmadeit aChristmastorememberfora Telfordfamilywithacoolcash prize.


Jon Gidney struck lucky whenhediscoveredhehadwon theultimateprize from Tenpin–a£10,000cheque.Tenpin hadbeenofferingitscustomers acrossthecountryachanceto


wincashprizesasathankyou fortheircustom
Mr Gidney posted a heart-warmingvideoofhim andhissonplanningatripto Tenpin in Telfordtowin him thegiveaway. To be in with a chanceofwinningthegenerous cashprize,bowlingfansacross thecountry visitedtheir local
Tenpin,createdavideoorphoto oftheirtimeinthevenue,and posteditontheirsocialmedia


Jon said:“I’msoproud to havewonthiscompetitionwith myson.Ralphisthreeyearsold, lovesbowlingandwe’vebeento Tenpinmanytimes.Thankyou, Tenpinforcreatingthisunique competition.”

ShropshireBathroomsKitchens&Tiles Unit7,KetleyBusinessPark,TelfordTF15JD Phone:01952256683 www.shropshirebathrooms.co.uk CompleteBathroomInstallationRenovations Plumbing,Tiling&Electrics, KitchenSales&Fitting Completebathroommakeovers including3Ddesign Specialistinwetroominstallation &easyaccessequipment EverythingyouneedforaPerfect BathroomorKitchen Visitustodayforallyourbathroomneeds
NEWS TELFORDJOURNAL | THURSDAY, DECEMBER 8, 2022 2
Pet of the Week –Page 13 TV Guide –Page 21 THISWEEK
Stephen andSallyJohnson
SEVEN-DAYFORECAST Thursday Friday Saturday Sunday Monday Tuesday Wednesday 2°/-2° 3°/-2° 3°/-1° 3°/-1° 3°/0° 3°/0° 3°/0° Low/high
Jon and his son,three-year-old Ralph,receiving the chequefromTenpin employees
DozensofNHS“traf
Domestic abuser is jailed


This is thefaceofa domes ticabuserwhowasjailedforfive yearsforattackingwomen,later sendingoneofhisvictim’sletters whileawaitingtrial
Connor Buchanan,fromTel ford,was foundguiltyand sen tenced at Shrewsbury Crown Courtforhiscrimes
Thecourtheardhowbetween MaylastyearandJunethisyear, Buchanan hadseriouslyassault ed twowomenon twoseparate occasions.Hewaslaterarrested andcharged.Buchanan, now21,
continuedtointimidateoneofthe victimswhileincustodybysend ingherlettersregardinghisup comingtrial.
Buchanan,ofWallettDrivein Muxton,wasfoundguiltyofcaus inggrievousbodilyharm,assault occasioningactualbodilyharm, controllingand coercive behav iourandtwocountsofwitnessin timidation
Allofthe sentences will run consecutively,totalling60months. He wasalsogiven a10-year re strainingorder
Atotal


withtheaimofmanagingdemand.
Thedatawillbeusedbystaff whowilldivertambulancesaway from full hospitalstooneswith morespace
Onesuchcentre,alsodubbed a“winterwarroom”,hasbeenim
plementedbyNHSShropshire,Tel fordandWrekin.

Itwillrunsevendaysaweek, fullymannedduringdaytime hourswithon-callarrangements overnight.

SamTilley,directorofurgent andemergencycareandemergen cy planning forNHS Shropshire, Telfordand Wrekin,said: “For thelastcoupleofyears,sincethe Covidpandemic,wehavebeenex periencingpressuresonservices acrossthewholehealthandsocial caresystem
“Thesepressures canstrike differentpartsofthesystematdif
ferenttimesorintandem.
“This couldbedemandfor ambulances, increasesinpeople walkingintoA&E,demandforcare homebeds,orforprimarycareap pointments.
“This newcontrol centre is apositivestepforwardandwill allowstafftosee‘real-time’data fromacrosshealthandsocialcare enablingustosee whereambu lancequeuesarebuildingup,wait ingtimesareincreasing,bedoccu pancyischallengedforinstance, andtoworktogetheracrossthe systeminajoined-upwaytoad dresstheseissuesquickly.”

Worstfor 999 wait times
Shropshireand Telfordhave thelongestambulancewaittimes intheregion,newresearchhasre vealed FiguresuncoveredbytheLib eral Democratshaverevealeda postcode lotteryofambulance waittimesacrosstheWestMid lands,withpatientsinShropshire waitingonaveragemorethanfive minuteslongerforlife-savinghelp thanthoseinBirmingham Theresearch, uncoveredby
theLibDemsthroughFreedomof Informationrequests,revealshow patientswhoselivesareinimme diatedangerarewaitingtwiceas longinsomeruralpartsofthere gionasinurbanones.
Category twocalls,including potentialheart attack or stroke patients,inShropshireandTelford &Wrekinarewaitingforanaver ageof49minutesforparamedics toarrive–morethanhalfanhour overthetargetresponsetime(18
minutes).For themostserious calls,patientsinthecountywaited foranaverageof11minutesand 31 secondsfor category onere sponses,comparedtosixminutes and20secondsintheBlackCoun try.AspokespersonfromtheWest MidlandsAmbulanceServicesaid: “Sadly,thepressureswearesee inginhealthandsocialcarelead tolonghospitalhandoverdelays “Theresultisthatourcrews aredelayedinreachingpatients.”

Wedon’thavebigflashyadvertsorpushy salesman;we’reafriendly,localand ethicalfamilyrun-business. Weguaranteetobuyanyproperty,inany location,inanycondition,veryquickly withcash. We’llpayallyourfeesandthereare noviewings,boards,advertsorhidden charges. Giveusacallforaninstantguaranteed valuation.Wecanhaltrepossessions andhelpfixyourdebtproblems. Wecanbuytoday. WOULDYOULIKEMETO BUYYOURHOUSE? CallRamonanow01952301953 CARPETCLEANING AVAILABLE Email: directblinds1988@aol.com |Web: www.directblindsshropshire.co.uk EST 1988 30 yrs EXPERTISE! ALL TYPES OF QUALITY BLINDS, CURTAINS, SHUTTERS &AWNINGS FREE MEASURING &FITTING SERVICE FOR YOUR HOME,CONSERVATORY,OFFICE CALL US ON 01952 291 267 Beautiful showroom arrangedover 2floors arranged over Grate G fir ep la ce cen tre Open Monday -Saturday9am -5pm Sunday10.30am -2pm Castle Trading Estate, HolyheadRoad, Priorslee,TelfordTF2 9NP tel: 01952620189 www.grateideas.co.ukemail:info@grateideas.co.uk Extensive rangeofsolid fuel stoves. Full installation service available WINTER WARMERS NEWS THURSDAY,DECEMBER8, 2022 | TELFORD JOURNAL 3
has been implemented
NHS‘warroom’
ficcontrol
in Shrop
on
centres” includingone
shirehavegoneliveina bidto managethe intensepressure
thehealthservice
of 42 controlcentres acrossEnglandwillusedatasuch as A&Eperformance,waiting times,stafflevels,ambulancere sponsetimesandbedoccupancy
One of the42‘winter warrooms’ hasbeen launched by NHS Shropshire,Telfordand Wrekin
Connor Buchanan
Firmsbattleto find thestaff that theyneedtostayalive
It’satoughtimeformanybusinesses.Oftheissuestheyface,find ingthe rightkindofstaff is now amongthebiggest.
Brexitbroughtchallengesasdid negotiatingapandemic.Andfirms alsofacerisingenergypricesanda cost-of-livingcrisis

Now,ontopofallthat,firmsare wrestlingwithhiringchallengesset togointo2023andbeyond.
ArecentShropshire Chamber of Commerce survey revealed that 76percentofthosebusinesseswho respondedarestrugglingtorecruit. Anotherfromthe Federation of SmallBusinessesreinforcedthat–in fact78percentsaidtheywerefind ingithardtobringinnewstaff

RichardSheehan,thechiefexec utiveofficeroftheShropshireCham ber,saysrecruitmentisnowa“major issue”inthecountyandbelievesthe pandemic hasplayeda significant roleintherecruitmentchallenge.


He believes thewholeethos of
By MatthewPanter
recruitmenthaschangedasaresult ofpeoplebeingforcedtoworkfrom homeduringlockdowns
“Thepandemic haschanged people’srelationshipwiththework placeinmanycases,”hesaid.“There arealotofvacanciesthatcompanies arestrugglingtofillsimplybecause they can’taccommodateaworkfrom-homeenvironment
“The‘workingfromhome’factor issomethingwhichhasbecomealot moreimportanttoalotmorepeo ple.It’stakenbusinessesalongtime to realisethat, actually,theyhave tosellthemselvesnowbecauseitis suchatightlabourmarket
“It’salmostareversalofthepast We areinasituation nowwhere nolongerdopeopleapplyforajob andit’sjustabout them having to sell themselves.Businesseshave todothesame.Thepandemichas
changedpeople’swholeattitudeto wardsworkandtheworkplace.The migrantlabourissue hasaffected ushereinShropshiretoo,especial lywiththesectorswehavesuchas thosesurroundingagriculture,tour ism,leisureandhospitality.
“Theyhavebeenhitreallyhard bythelossofthatlabour,there’sno question,andwehavebeenflagging thatupformorethanayearandpro gressneedstohappen.”
HollieWhittles,humanresourc esdirectoratTelford-basedPurple FrogSystems,isaleadingfigurein theFederationofSmallBusinesses andhas also reflected on recruit mentasa“massiveproblem”
“FromthediscussionsIamhav inginShropshire,businesses just can’t findthe rightstaff with the rightskills,intherightplaceatthe righttime,”shesaid.“Wearearural areaandbusinessesarebeinghitby allmannerofrisingcosts,sorecruitmentontopofthatisamassiveprob
lem. We have anever-before-seen situationwherethenumberofjob vacanciesishigherthanthenumber ofpeopleunemployedorlookingto changecareer.
“Thepandemicledtonewwork practices and flexibilities, which manypeoplearereluctanttoleave behind.Manyofthosewhoarelook ingforworkareholdingoutformuch higherpayandmuchmoreflexible workingarrangements.
“Manyworkers in traditionally lowerpay,high-stress industries, havedecidedtochangecareeralto gether,creatingevengreatershortagesinareassuchascare,hospitality andretail.”Holliesaysthat,moving forward,astrongerrelationshipis neededbetweenbusinessesanded ucationinordertotrytopromote opportunitiesandcareers.
“Wefound in oursurveythat only17percentofbusinessesare engagingwithschoolsandcolleges,” Holliesaid. “Sometimes, insteadof
leavingittothebigbusinesses,we needtoencouragesmallerbusiness estospeakupandcommunicate.”
GrahamGuest,principalofTel fordCollegeandskillschampionof theMarchesLEP,saysthatlinkbe tweeneducationandbusinessisvi tal,movingforward
“Asacollege,wehaveseenthe challenges,” he said.“We recruit teachingstaffbut,withregardsto otherstaff,itbeenastrugglesowe feeleveryone’spain
“Whatwearebeginningtosee isbusinesseswithalong-termplan, lookingtoworkwithschoolsandcol legestocreateapipelineofrecruits andthat’sreallypositive.Withwork experience andapprenticeships there’sa plethoraofopportunities foremployerstogetinvolved.There arelotsofinitiativesandhopefully business andeducation canwork togethertomeetthechallenges.The morebusinessesthatengagethebet ter.”
Successofknife campaign
Apoliceoperation to prevent knifecrimehasbeenhailedasasuc
cess.
Operation Sceptre, anational week of intensiveaction to tackle knifecrime,ranfromMonday,No vember14to20
Forthe scheme,WestMercia Policeranaseriesofeducationand engagement activities,designed to raiseawareness of thedangers of carrying aknife. This included 28 community events, reaching over 12,000people,and74schoolvisits reaching over 18,000 children and youngpeople

Thetouring anti-violencebee alsoprovedtobeaparticularlypop ularattraction.Asidefromtheedu cationinitiatives,policeofficerscon ducted82weaponsweepsandrana
knifeamnesty.Asaresult,thepolice say,105knivesandbladedweapons havebeensafelycollected,prevent ingthemfromreachingthestreets
Policeofficers,alongsideTrading Standardsofficers,alsoworkclosely withlocalretailers.Duringtheweek, policevisited85retailersandcar riedout50testpurchases
WestMerciaPolice’sknifecrime lead,ChiefInspectorHelenKinrade, said:“Operation Sceptreisanim portantweekofactionthathelpsus raiseawareness of thedangers of carryingaknifeandtohavereached over30,000peoplewithourearlyin terventionandengagementworkisa fantasticresult
“However,it’simportanttonote thatourworkcontinuesbeyondthis nationalweekofactionandourof
ficersareworkingeverydaytore ducethenumberofknivesbeingcar riedandthenumberofpeoplebeing hurtbythem
“Asalwaysthepublichasavery importantparttoplayinhelpingto keepknivesoffourstreets.Theycan helpusasextraeyesandearsinour fight againstserious violenceand knifecrime,andbymakingareport tousyoucouldhelpsavealife
“Ifyouareworriedthatsomeone youknowiscarryingaknife,please reportit.Wecanthentaketheneces sarystepstosafeguardthem.”
Knife-related crimecan be re portedtothepoliceonlineorbycall ing101.Youngpeoplecanalsoaccess non-judgmental information and advice throughthe Crimestoppers charity,fearless.org
GrahamGuest saysfirms mustworkcloser withcolleges
infuture Hollie Whittles has reflected onrecruitment asa‘massiveproblem’ RichardSheehan
NEWS TELFORDJOURNAL | THURSDAY, DECEMBER 8, 2022 4
Theissues arediscussed
The ManchesterAnti-Violence Bee visitedschools
Awarmwelcome is alwayssoimportant
You’re welcome.It’ssomething weoftensaywithoutthinkingabout it
Afriendthanksusforacupof teaoralifthome.You’rewelcome Sometimeswesayitwithabitofan edge,evensarcasm.Wehelpoutand there’snogratitude.You’rewelcome, andaflounce.
Ifwestoptothinkaboutitfora moment,helpingsomeonefeellike theyreallyarewelcomeisoneofthe mostimportantthingsthatwecan doforthem
Makingsomeonefeelunwelcome canhaveamassiveimpact,justask LadySusanHussey.

Iwonderwhathelpsyoufeelwel comeinanewplace,withnewpeo ple.
Iwonderhoweasyyoufinditto welcomenewpeopleintoyourspace.
Ithinkthatthechurchneedsto faceuptothefactthatwehaven’tal waysbeenverygoodathelpingpeo plefeelwelcome



Perhapsifwe’dbeenbetterat it,thenthe latest Census returns wouldn’thaveshown that forthe firsttimeinseveralcenturies,less thanhalfthepeopleintheUKidenti fythemselvesasChristian






Wedon’thaveanyexcuse.When wereadtheaccountsofJesus’life intheBible,hewasalwayshelping
WORKINGFOR YOU
With RevTim Carter
peopletofeelwelcome.Hegotangry withhisfriendswhentheytriedto stopparentsbringingtheirchildren toJesusforablessing.Hespenttime withthoseontheedgeofsociety
Hecametobringaradicalinvita tionofwelcometoeveryonetogetto knowhim,andtoenjoylifeinallits fullness
That’s what we celebrateat Christmas.
Aswereadthefamiliaraccounts ofthefirstChristmas,wehearthe themeofwelcomerunningthrough them
Mary’swelcomeofJesusintoher womb.Joseph’swelcomeofJesusas hisadoptedson.Theshepherd’swel comeofJesusasthefulfilmentofthe promisesofGod.

ThisyeartheChurchofEngland’s publicityfeaturesthe line, “You’re verywelcomeatchurchthisChrist mas. ”
Ihopethatyouwillexperience that welcome this Christmas, and thatyouwillknowthewelcomethat Jesusoffersusall.
Clinician supporting hospitalsshake-up


Moving with times
TALKINGTELFORD
 WithRob Smith
WithRob Smith
There’sawelcomenewdevelop mentinWellington–anditmightbe justintimeforanexcitingChrist mas.

Thescaffolding at thenarrow endofMarketStreethasfinallydis appeared,so(mostof)theglorious newroadsurfaceisavailabletosee atlast.Theworkgoingonatthatcor nerofthemarketsquarehasbeen noisyandtookitstime,buttolookat itnowistoseesomethingmoreakin toareallymoderntowncentre
It’sashametheviewispartially blightedbythederelict,boarded-up unitbehindCaprino’spizza.Andof course thereisstill work ongoing furtherdownMarketStreetsothe sceneisn’tquitecompleteyet.Tel ford&WrekinCouncil’sroadworks teamthinkitshouldallbedoneby February9nextyear,bywhichtime thecentreofWellingtonmayhavea verydifferentlookaltogether


MarketStreetitselfhasalready beenthroughalotofchangesinthe last 60 years –looking at theat tachedpicture,it’sstrangetothink thattheseoldunitsthatoncehoused traditionalbrandsarenowhometo vapeshopsandphonerepaircentres

(notthatI’mcomplaining–asaper petuallyclumsypersonI’vehadto callonthatverysamephonerepair shopmorethanonce)









Therewas plentyofoptimism atarecentmeetingofmindsinthe townorganisedbyLoveWellington todiscussideasforfuturegrowth. Traderscameandsharedtheirplans, concernsandtheirideas-including anelectricbikedeliveryscheme
Amongtheideasdiscussedwas moreopportunities forlatenight shoppinginthetown–hardlysur prisingafter thesuccessful recent introductionoftheSaturdayevening marketexperiences, whichfrom allaccountshavegonedownlikea





houseonfire.Livemusicandquality streetfoodinacoveredmarket?In Digbethmaybe,butsurelynotWel lington?
Iwenttothemarketonlyrecent lyforthefirsttimeinyearsandwas veryimpressedbythecoveredsec tionwithallkindsofpurveyorsof streetfoodcrammedintogether
Wellingtonhasanabundanceof freeparking,anhistoricmarketthat managestomovewiththetimesand anextremelyswitched-oncohortof business owners whoseemdeter minedtomakethemostofwhatthey have.CouldWellingtonsoonbechal lengingShrewsbury’sreputationfor aqualitymarketdayexperience?
Atopclinicianinthecountyhassaid thecontroversialhospitalstransforma tionprogrammewilladdressdelaysin urgentandemergencycare
SubramanianKumaran says the currentset-upattheRoyalShrewsbury andPrincessRoyalhospitalsisbecom ingincreasinglydifficultfor patients andstaffalike.

Akeycomponentofplanstoshake upacutehospitalservicesacrossShrop shire,Telford&WrekinandMidWales involveschangingtheShrewsburysite tospecialiseinthedeliveryofemergen cycareandthedevelopmentof24/7 enhancedurgentcareservicesatboth hospitalsites.

MrKumaran,clinicalleadforemer gencycarefortheHospitalsTransfor mation Programmeand emergency
medicineconsultant,saidthechanges wouldbringtogetherspecialistteams sothatpatientsareseenfasterandin therightplace,leadingtoaquickerdi agnosisandshorterhospitalstays

Hesaid:“Istrivetodeliverthebest careforpatientsandwithourcurrent serviceset-upthisisbecomingincreas inglydifficult.




“Weneedtochangethe wayour servicesaredeliveredsothatwecan addressthedelaysthatourpatientsare facingandthechallengingconditionsin whichourstaffwork.
“Theplannedservicechangeswill deliverrealimprovementstoboththe urgent andemergency care received byourpatientsandwillassistusinat tractingandretainingmoreofthespe cialiststaffweneed.”























Join us at AbleworldNewport ALL PROCEEDSOFT RAFFLE WILL GO TO LOCALMENTAL HEAL CHARITY-NOPAN TUESDAY 13TH DECEMBER FOROUR CHARITYCOFFEE DAY &HAMPER RAFFLE ON FREE REFRESHMENTS ANDCAKE VOTED MOBILITY RETAILER IN THEUK NO.1 Further details on all our storescan be foundon: www.ableworld.co.uk NEWPOR T AB LEW ORLD Audley Avenue BusinessPark, Newport,Shropshire, TF10 7BX Tel: (01952) 820772 newport@ableworld.co.uk Behind Aldi 1 8
Wellington’s MarketStreet haschanged alot in the last 60 years
OPINION THURSDAY,DECEMBER 8, 2022 | TELFORDJOURNAL 5
Mr Kumaran supportsthe planstorestructure thehospitals
Aldiistriallingclearcapsonmilk bottlesinitsShropshirestoresina bidtofurtherimprovetherecycla bilityofitsproducts
Thesupermarket is scrapping thegreenbottletopsonitsBritish SemiSkimmedStandardMilkprod uctsinfavourofclearcaps,which areeasiertorecycle
Thetrial,whichisinpartnership withmilksupplierMüller,wasintroducedlastmonth
If successfuland rolled outto allMüller-suppliedstores,anadditional60tonnesperyearofrecycled High-Density Polythene(rHDPE) couldbeturnedbackintofoodgrade packaging.RichardGorman,plastics andpackagingdirectoratAldi,said: “Weknowit’sbecomingincreasinglyimportanttoourcustomersthat theireverydayproductsareenvironmentally-friendly, andwe areconstantlyreviewingwaystobecomea moresustainablesupermarket.”
Clearcaps forAldimilk Driversstay outof lane
Nearly half of driverssay they frequentlyoroccasionallyavoidus inglaneone on smart motorways withoutahardshoulder,anewsur veysuggests.
TheRAC,which commissioned thepollof1,904motorists,claimed theresearch“completely under mines”themainreasonforturning hardshouldersintorunninglanes, whichwastoboostroadcapacity
Afifthofrespondentswhohave driven on theseall-lanerunning smart motorwayssaidtheyfrequentlystayoutoftheleft-handinsidelane,while28percentsaidthey dosooccasionally.Askedwhythey deliberately avoid drivinginlane one,77percentsaidtheyarewor riedtheymayencounterastationary vehicle.Almostthreeinfourpeople questionedsaidtheywouldfeelsafer ifthereweremoreemergencyrefuge areas.
Robots set to spot UTIs
Residentsincarehomescould besomeofthefirsttobenefitfrom aprojectwhichaimstouseartificial intelligenceandrobotstodetecturi narytractinfections(UTIs).
ResearchersfromboththeUniversityofEdinburghandthecity’s Heriot-WattUniversityareworking together on theFeather initiative, whichseekstoreducesomeofthe negativeconsequencesoflatediag nosisofUTIs.
Theexpertleadingthescheme, Professor KiaNazarpour from the University of Edinburgh, said it couldeventuallyreducethe numberofpeopleattendingaccidentand emergencywithinfections,aswell as helping to tackle theover-prescription of antibiotics. Some 150 millionpeopleayearworldwidecan sufferfromUTIs,makingthemone ofthemostcommontypesoninfection.Whendetectedearly,UTIscan betreatedwithantibiotics.
Offering dementia help

Anewnursingservicehasbeen launched to help supportfamilies livingacrossShropshireaffectedby dementia
Theservicewillconsistofateam of four specialist dementia nurses calledAdmiralNurseswhowillprovidelife-changingsupporttofamiliesaffectedbyallformsofdementia
Theirexpertisecanhelppeople livingwithdementiastayindepend entforlonger–andsupportthepeoplecaringforthemsothattheywill havethestrengthtocopewiththe baddaysand theenergytoenjoy
thegooddays.Theservicewillbe launchedaspartoftheShropshire, Telfordand Wrekin’s Dementia Transformation Programme andis hosted by Shropshire, Telfordand WrekinIntegratedCareBoardincollaborationwithShropshirePrimary Care Networks (PCNs),Shropshire Community Health NHS Trustand DementiaUK
Clinical lead formental health, DrPriyaGeorge,said:“Gettingadementiadiagnosiscanbeahugeshock topatientsandtheirfamilies,who oftenstruggletoacceptwhatishap-
peningandthedifficultiesitbrings
“This smallteamcan make a bigimpact,notjustforpatientsbut forcarerswhocanbecomeisolated andhighlystressed.AdmiralNursesmakearealdifference,offering adviceandlinkingfamiliesupwith respitecareandotherservices.”
Emma Butler,ShropshireAdmiralNurseteamleader,said:“The ShropshireAdmiralNursesareex tremelyexcitedtolaunchthisserviceforfamiliesinthecountywho areexperiencingdifficultiesdueto theimpactandeffectsofdementia.”
Airman’s lost warmedalswing theirway back to family again
Remarkabledetectiveworkand afundraisingcampaignhadseenthe medalsofaWorldWarTwoairman returnedtohisfamily.
SteveTaylorfromMarketDraytonwasdeterminedtotrytofindthe medalsofhiscousin’sfather,Godfrey DennisThomas,soldafterhisdeath in 1982.Theyincluded theDistinguishedFlyingmedal.
Afterpainstaking research he foundthattherewerebeing auctionedinthesouthofEnglandbut, whenhecontactedtheauctionhouse discovered they hadalreadybeen sold.Hethenmanagedtotrackdown thenewownerofthemedalswho agreetosellthemtoSteve.“Ican notthankthispersonenough,”Steve said.“WhenIexplainedhewashap pytoletmehavethemedalsforthe marketprice.”
Steve,69,raisedthemoney,more than£3,000withasponsoredswim clockingup6,194lengthsatMarket Draytonswimmingandfitnesscen tre. Thesenumbers represent an amalgamation of Godfrey’sSecond WorldWarflyingrecord.
Steve,whohimselfservedfrom 1973to2000intheAircraftAvionics branchretiringasachieftechnician wasabletopassonthemedalstohis cousin,IrisThomasattheRoyalAir ForceMuseumatCosford
“I metupwithmycousin, Iris Thomas;herdaughter,Nadine;her
granddaughter, Meghan andher greatgranddaughter,Charlotte.It wasquiteanemotionaleventmade allthemorespecialbecausethecu ratoroftheMidlandsbranchofthe RAFMuseumatCosford,DarrenPri day,allowedusaprivateviewingof themuseum’sHandleyPageHamp denbomber.Itwasthisaircrafttype thatGodfreycompletedallofhis32
missionsfromwhichheearnedhis DistinguishedFlyingMedal.”Infact theaircraft wasfromasquadron thatGodfreywasattachedtofora time.Hemayevenhaveflowninthat aircraft.” Attached to themedals wasagoldCaterpillerClip,givento thoseintheairforcewhohadhadto bailoutanduseanIrvinparachute, somethingthatGodreyhad to do
“Godfrey hadkeptthe D-ring and thestringthatwasattachedtothe parachutethatsavedhislifeandthe familystillhaveit,”Stevesaid.“That andalotofphotosandothermemorabiliawiththemedalscannowbe keptforgenerationstocome.”
Moneyleftoverafterbuyingthe medals will be giventothe Royal BritishLegion.

Plea over keepingbirdfeedersclean
Nearly9,000callstotheRSPCA aboutsickorweakgardenbirdshave prompted apleafor bird-lovers to cleantheirfeedersregularly
Asautumnturnstowinterand bird-lovers step up supplementary feeding,datafromtheRSPCAhigh lights just howvulnerablegarden birdscanbetoillhealth.
Thecharityreceived8,750calls aboutsickorweakgardenbirdslast year,andwiththehelplinestruggling withanunprecedentedhighvolume ofcalls,itisaskingthepublictohelp maintainthehealthofgardenbirds
Whilstonly52ofthosecallscame from Shropshire,a spokesperson fromthecharitysaidthatthisyear’s birdfluscareisatimelyreminderof thedevastationthatcanoccurfrom contagiousdiseases.
Whilebird flu doesn’t tend to affect gardenbirds, stepstopreventhighlyinfectiousdiseasesfrom spreadingthrough abird popula tionareessentialwhateverthespecies.Thecharityhasrecommended cleaningfeedersweeklyandwater containerseveryday
Feedersshould also be rotat-
edaroundthegardentokeepbird droppingsandbacteriafrombuildingup,andfeedingareasshouldbe keptraisedabovethegroundtodetermice.
RSPCAscientific officer Evie Buttonsaid:“Birdscandiefromdis easescaughtfromdirtyfeedersand waterbowlssoit’sreallyimportant tokeepgardenbirdfeedersclean.”
“Lastyear,wetookalmost9,000 callsfrompeoplereportingsickor weakgardenbirds
“That’salreadyfartoomany,but sadly,thatfigureislikelytobejust
thetipoftheiceberg;manybirdswill becomesickandwilldieunseenby humans
“It’sreallyheart-warmingthatso manypeople–aroundhalfthepopu lation–wanttohelpgardenbirdsby feedingthem.Butthisdatasuggests thatbirdsarenotashealthyasthey shouldbeandonewaywecanmake adifferenceisgoodhygiene
“While bird flu thankfully doesn’ttendtoaffectgardenbirds veryoften,it’satimelyreminderof thedevastationthatcanoccurfrom ahighlycontagiousdisease.”
Report by Sue Austin
NEWS TELFORDJOURNAL | THURSDAY, DECEMBER 8, 2022 6
IrisThomasallsmiles afterbeingreunitedwithherfather’swar medals
AdmiralNurses willprovide life-changing support

VOTED MOBILITY RETAILER IN THE UK NO.1 www.ableworld.co.uk Voted UK’s no.1 Mobility Retailer 2019, by Access &Mobility Professionals NHS Vouchers Welcome Where Applicable *VAT Exempt -Ask for Details MRP- Manufacturers Recommended Price Previous Price -Sold for 28 days in onths at our Nantwich Store Insurance/Warranty is arranged by Ableworld UK Ltd and provided through Mark Bates Ltd t/a Premier Care, Premier House, Londonthorpe Road, Grantham, Lincs, NG319SN who are authorised and regulated by the Financial Conduct Authority. FRN308390. Calls made to this number may be recorded for monitoring and quality purposes FREEPH 0800 54 STAIRLIFTS RECONDITIONEDSTRAIGHT FROM £495 NEW STRAIGHT FROM £1495* NEW CURVED FROM £3295* £369 FROM ONLY RISER RECLINERS 3LUCKYCUSTOMERSWILLWIN BACK THE COST OF THEIRSTAIRLIFT CheshireDeluxe ST STAIRLIFTS FITTEDBEFORE CHRISTMAS Wall Clock • Greataid foranyonelivingwith Dementia • Clear numbers anddistincthands,making it easytoread • Dislaysthe day, date andmonth in UK format GIGREATFTIDEA SAVE £10 CRACKIN’PRICE £16.99 HUGE SAVING SAVING £200 • Luxurious chair offers ultimatecomfort • Available in Waterfall,Buttonand Lateralstyles • MaxUserWeight: 15-25 stone CRACKIN’PRICE £1149* CRACKIN’PRICE JollyBootScooter CRACKIN’PRICE £599* • Dismantles into 5-parts • MaxRange:10miles • MaxUserWeight: 21 stone SAVING £200 STNEW CUYLEOF SHION DELIVERED Strolley Trolley • Ideal fortransferring meals &otheritems aroundthe home • Clip on/off traysfor easycleaning • Fullyheightadjustable to suit the users needs SAVING £40 CRACKIN’PRICE £59.99* I-LiteTravelchair • Ideal foroccasiona • TotalWheelchair .73 st • MaxUserWeigh SAVE £80 CRACKIN’PRICE £139* CRACKIN’PRICE Anti-Vibration ScooterAlarm • Deterrenttopotential theft • Wireless rangeof10to20metre SAVE £5 CRACKIN’PRICE £19.99 DerbyTap Turner • Ideal forthose with Arthritis or limited hand dexterity • Colour coded in redand blue SAVING £5 CRACKIN’PRICE £17.99
Couldwelcome returntohigh streets be onthecards aswe tire ofclicking?
Is ourlove affairwithonline shoppingonthewayout?
Thesignsareshoppersarebe cominglessclick-happyastheylook totakecareoftheirfinances
Andwiththatmorehesitantapproachcomesadesiretotravelback toshopsagain,tophysicallycheckon goodsandensurequalityandvalue formoneyisright.
Accordingtoexperts,almost halfofgiftshoppingbypeopleinthe WestMidlandswillbedoneinstores andhighstreetsthismonth
That signalsa welcomereturn tothehighstreetandwithitaboost fortownandcitycentresthathave increasingly struggledtocompete withtheconvenienceofonlineshop ping,especiallyafteraCovidlock downinwhichpeoplegotoutofthe habitof‘goingshopping’.
PricewaterhouseCoopers’annual FestivePredictionsreport, publishedlastweek,hasfoundthatwhile thepandemicacceleratedtheshiftto
onlineshoppingforChristmaspre sents,therehasbeenarecoveryin thepreferenceforshoppinginphys icalstores
FollowingBlack Friday,where PwCresearchfound that 43 per cent of West Midlands consumers wereinterestedinspendingonthe day,itispredictedthatconsumers areplanningtoslightlyreducetheir festivespendingthisyear,withan averagespendof£393peradultin theUK,eightpercentlessthanlast year’s£426.Butmoreofthemoney beingspentwillbehandedoverat tillsratherthanthroughthemobile phoneorcomputerscreen.


SarahPhillips,PwC consumer leaderfortheMidlands,saidmajor shoppingcentres,suchastheBullring,MerryHill,TelfordandShrews buryshouldseeabenefit
Shesaid: “Footfallshouldin-
creaseacrosshighstreetsinthere gionthisChristmas.Bigeventslike thereturnoftheBirminghamGermanMarket,aswellasotherfestive attractionsputonagainintownand city centresacrossthe West Midlandswillbringpeopleinandthat willhaveapositiveimpact.
“Whilstaveragespendperconsumerinthe UK is predictedto slightlydecline,45percentofthose intheWestMidlandsareplanningto headinstorefortheirfestiveshop ping,providingaboosttoretailers andhospitalityvenues.”
PwCresearchshows that this year many consumersusedBlack Friday as an opportunity to start Christmasshopping,looking to make useofdiscounts when look ingforgiftsasthecost-of-livingputs pressureondisposableincome
MsPhillipsadded:“Thismeans that spending during December is likely to be lowerand retailers shouldhelptheircustomersecono
mise,whilekeepingChristmasspe cial.Christmas dinner –and food anddrinkmoregenerally–remain thekey spending priorities, with almostasmanypeoplesayingthey willspendmoreasspendless
“Ourresearchshowsalmosttwo thirdsofpeopleinthe West Midlandswill be hostinganextended orimmediatefamilygathering,the highestproportionintheUK,showingthataftertwoyears’ofrestric tions,spendingtimewithlovedones isapriority.”
Retail experts also pointtoa growingcynicismamongshoppers atthelevelofdiscountavailableon lineandwhetherthesavingsbeing advertisedaregenuine Pricecomparison websitePriceSpysurveyedthetrendsinprices intheperiodaheadofBlackFriday andnoticedthatonlinepriceswere artificiallyincreased in theweeks aheadoftheeventsothattheycould then be advertised as discounted
whenthesalesstarted.Thistactic ofpreparingfor‘fakesales’ispart of an increasing trend. Around 14 percentofproductstrackedbyPriceSpyincreasedintheweeksaheadof BlackFridayandthenweresuddenly ‘reduced’.
Figuresfor2021showthatbeau ty wasthe worst-affectedsector, with22percentofallperfumesand 21percentofallskincareproducts featuringinfakesales.Othersin cludedcomputercomponents(18 percentofallproducts),hikingand trekkingfootwear(16percent)and kitchenappliances(15percent).
“Our data indicatesfakesales onBlackFridayin2022mayhave been much morewidespread than inrecentyears,”saysLiisaMatinv esi-Bassett,thewebsite’smanager Consumer magazineWhich? goesfurther–itfoundthat99.5per centofproductsinsupposedBlack Friday ‘deals’ were cheaperorthe samepriceatothertimesoftheyear
WE’VEGOT THE TALENT *ExcludesVAT To get started call 01902 319856 today or visit www.staremploymentservices.co.uk Find your ideal candidate with our fixed price recruitment packages starting from £345*
By John Corser
FEATURE TELFORDJOURNAL | THURSDAY, DECEMBER 8, 2022 8
Shrewsbury’s town centrecouldsee abenefitinthe runuptoChristmasAccording toexperts,almosthalfofgiftshoppingwillbedone instores
Collegeoffersaworld of possibilities
TelfordCollege offers alively andsupportive campus that hasbeen purpose-builttooffer awiderange of course choices, includingaca demic, vocational,apprenticeshipsand more.
Tlevel courseswill be offeredin September 2023.The newvocation-
COMMERCIAL FEATURE

al qualificationsare the equivalent to threeA-levelsin UCAS points andrecognisedbyall universities

Initially, thecollege will be offeringT levels in health, scienceand digital.
TelfordCollege’s apprenticeship team is continuouslynetworking with localemployerstogivestu
dentsachancetogainvaluable qualificationsalongside real-world workexperience
Part-timeadult learning courses areoffered forthose whofancy a career change or maynot have had theopportunitytodo so when they finished school

Coursesrange from level 2-5, and includeaccounting, education, hair dressing,healthand socialcareand humanresources.
If you can’tordon’t want to phys ically go to college, thereare several shortcoursesthatcan be done on line whereyou will gain alevel 2or 3qualification
Thecollege’s next open eventis on Wednesday,November 30 from 5pmuntil 7.30pm
Theadult open eventisonSatur day,December 10 from 10am until 12.30pm,where TelfordCollege are offering free flujabstoany adult
whoattends theSaturdayopen event.
To book on either open eventsee www.telfordcollege.ac.uk/join-us/ open-events/our-open-events/


If you’dpreferamorein-depth look at thefacilities TelfordCol lege hastooffer,orifyou’refeeling anxiousabout starting college, you canalso booka1:1 tour by emailing marketing@telfordcollege.ac.uk or by calling 01952642200.



10th December 2022 10am to 12.30pm
Are youlooking to upskill your staff, start anew career or justimprove your skills? Find out about our full-time, part-time and distance learning courses. Start your weekend with abreakfastbap, amince pie, ahot drink and meetthe friendly college staff FREE FLU JABS* forall adults whopre-book online and attend Book to attend today www.telfordcollege.ac.uk |Haybridge Rd,Wellington, TelfordTF1 2NP *(service nottransferable)
Adult OpenEvent
EDUCATION 9 THURSDAY,DECEMBER 8, 2022 | TELFORD JOURNAL
ThecampusatTelfordCollege offers state-of-the-artfacilities andhas been purpose-builttooffer awiderange of course choices, including academic,vocational andadult learning courses
Building safer communities
With Julie Phillips
Thereare anumberofcam paignsrunningthroughoutthewinterseason,runbyWestMerciaPolice,NeighbourhoodWatchandlocal councilsacrossTelfordandWrekin
Thesefocus on stamping out violenceagainstwomen andgirls, avoidingfraud when purchasing Christmasgifts on line,keeping yourselfsafewiththenightsdrawingin,waystokeepsafeinthedark andthe dangersand oftentragic consequencesofdrinkdriving
It’s allabout building stronger andsafer communities,which you canplayabigpartin:bybeingan activebystander,interveningifitis safetodoso,bycontactingthepoliceandcaringforthepersonwho hashadacrimecommittedagainst them
Letthosewhomaybevulnerable inyourcommunityknowthatthey arenotaloneandyouasanindividualandcommunityarelookingoutfor themandeachother,tolendahelpinghandwhereit’sneeded
PartoftheremitofNeighbourhoodWatchisbeingabetterneigh bourandthisisallthemoreimpor tantoverthewintermonths.
Formoreinformation on how youcangetinvolved,visitwww.our watch.org.uk
Prideforsolicitorover anationalaward win
Report by Sue Austin

Asolicitorwhohasbeenaleadingvoiceincasesinvolvingmater nity services at Shrewsbury and Telfordhospitalshaswonanational award.
Beth Heath, of Lanyon Bowdler,hasbeennamedastheClinical NegligenceLawyeroftheYearatthe PersonalInjuryAwards,whichrecognisethe excellence of law firms andindividualsinthepersonalinju ryandmedicalnegligencesectorsall overtheUK.

Judgessaidthelawyerwasaris ingtalentinclinicalnegligenceprac tice,achievingbigthingsinashort spaceoftime. Shewas also know forherthoroughandorganisedap proach,andcaringandcompassion ateattitude

BrianEvans,managingpartner atLanyonBowdler,saidBeth’saward wasrichlydeservedandatestament tothestrengthandcommitmentof thewholeclinicalnegligenceteam
Hesaid:“Ourcongratulationsgo toBethonagreatwinagainstsome stiffcompetition,includingthechief assessoroftheLawSociety’sClinicalNegligencePanel,andthehead of medical negligence from Slater &Gordon’sLondonoffice.Thisisa
brilliantachievementandiswellde served.IknowBethwouldsaythat shecouldnothavewonthisaward withoutthe supportofher team, sowithoutwishingtodetractfrom Beth’sstellarpersonalachievement, everyoneintheteamisawinnerfor thesupporttheygivewhichenables Beth andour otherclinicalnegli gencepartnersandseniorlawyers todowhattheydo.”Bethsaid:“Be
ingnamed as Clinical Negligence LawyeroftheYearisamajorhonour, whichI hopewill give ourclients evenmorereassurancethatLanyon Bowdlercan be trustedwithsuch sensitivecases.”
“Clinical negligence cases, particularlyonesinvolvingmaternity services,are understandablydis tressingandwealwaystakecareto supportourclients.”
Warningon drinkdriving
DriversinShropshirearebeing warnedtheyare50percentmore likely to be breath tested this De cemberthananyothermonth.
Analysis of HomeOfficedata by personal breathalyser firmAl coSenseshowsthatinDecemberlast year,WestMerciaPolicestopped721 motoristssuspectedofdrinkdriving.Thatcomparedwith486inan averagemonth
Atotal of 64 motoristsinthe WestMerciaareatestedlastDecemberwerefoundtobeoverthelimit Thefailurerateofninepercentwas justbelowthenationalaverageof10 percent
Policearenowsteppinguptheir campaignagainthisyear,targeting anyonetemptedtodriveunderthe influenceafterwatchingtheWorld CuporcelebratingChristmas
“Enjoyinganevening game, whetherathomewithfamily or downthepub,increasesthelikelihood of drivingthe next morning with alcohol still in yoursystem,” saysHunterAbbott,managingdirectorofAlcoSense
“Ifyoudrinkfourpintsofmedium-strongbeerorfourlargeglasses ofwineduringthefootball,itcould takeaslongas14hoursforthealco holtoclearyoursystem.
“Theruleissimple.Ifyou’vebeen drinking,don’t driveand if you’re driving,don’tdrink.Ifinanydoubt, self-testwithapersonalbreathalys ertoensureyou’reclearofalcohol.”
Firmsasked tohelp withUkrainemission


Twomenwhohavetakenpartinaid missionstoUkraineareurgingShropshirebusinessestohelpsupporttheir latestjourneytothewar-ravagedcountry.
Gary Fear and David Perryhave travelledtothe devastated country threetimes sinceRussianpresident VladimirPutinlaunchedabarbaricinvasioninFebruary.Thepair,delivering food,medicineandothersupplies,have witnessedall manner of devastation andaresettoreturnearlyinthenew year,aswinterkicksin
They hopetoraise fundstohelp supporttheirlatestmissionandhope businesses andindividuals mightbe abletohelp.“Itmightbegettingcolder
herebutimagineit’sbelowzeroandyou havenoelectricity,noheating,nowater andnofood,”saidGary.
“ManypeopleinUkraine areliv inginoralongsidetheremainsoftheir homes.Othersare living in disused schools, sometimescramped with 20 bedstoaroom–livingwithstrangers butsurvivingasbesttheycan.
“Thesepeoplearebrave,upstandingandproudoftheircountryanddon’t deservethis
“Theyfacetheprospectofanappallingwinterwheremanywilldiefrom thecoldandfromhungerandwereally needtohelp.”Anyonewhocansupport thepair’smission,candonateatjustgiv ing.com/crowdfunding/gfukraine
IsleofWightWeekend_E.pdf ISLE OF WIGHT WEEKEND Departing Fri 24 Feb‘23 Letuswhisk youaway to the Isle of Wight fora perfect weekend to relax and rejuvenate.Tailored forthose who seek adventurebythe sea and have adesiretoexplore! With an included visit to the historic town of Newport and an optional ‘Round the Island’ tour Your breakincludes Return coach travel and ferry crossings from Telford 3nights at the Channel View Hotel, Sandown with dinner &breakfast Entertainment on one evening Excursion to Newport Optional excursion to Cowes, Yarmouth &Ventnor (£10pp) 4Days by Coach only £139 Single Supplement £45 FOLKESTONE &COASTAL KENT -GOING SOLO Departing Mon 6Mar ‘23 Join us on ahassle-free trip to Folkestone,featuring a fabulous hotel and visits to Broadstairs and Margate; the perfect trip down memory lane! With everything takencareof, this is awonderful chancetoenjoy some sea air and exploreKent in friendly company. Your breakincludes Return coach travel from Telford 4nights at the Grand Burstin Hotel, Folkestone with dinner &breakfast 2for 1bar (6pm-9pm) on selected drinks Entertainment every evening Excursions to Broadstairs, Whitstable,Sandwich &Margate Going Solo hostatthe hotel Optional excursion to Canterbury (£12pp) 5Days by Coach only £249 No Single Supplement in association with Formoreinformation or to book, please call: or visit online at: 033numbersare free within inclusiveminutes packages otherwise standardrates apply Operated by JustGo HolidaysLtd.Coach package holidays and short breaks aresubjecttoJustGo! Holidays termsand cond tions. Your booking is p otectedbyBonded Coach Holidays (BCH) and the Association of Bonded Travel OrganisersTrustLimited (ABTOT); this is agovernmentapprovedconsumer protection scheme. Toursoffered subjecttoavailabilityand government guidelines.Errorsand omissions excepted. Prices perperson, based on twopeople sharing adouble/twin room. Calls to 033numbersare free within inclusiveminutes packages otherwise standardrates apply 03332 342 529 justgoholidays.com/WOL Quote WOL Your weekly newspaper AJ351757_v2_57
NEWS TELFORDJOURNAL | THURSDAY, DECEMBER 8, 2022 10
LanyonBowdlersolicitorBethHeathwiththeprestigious award
Gary Fear and Dave Perry withIgorBodnarchuk
NEIGHBOURHOODWATCH
Drone
AneweventiscomingtoTelford TownParkinDecemberwithTelford &WrekinCouncil’s We AreTelford FestiveDroneShowonWednesday,De cember21
Theeventwillfeaturea15-minute displayofover400dronescreatingim agesintheskyrelatingtolandmarks andeventsinTelfordandWrekinand willbeaccompaniedbyasoundtrack writtenbyTelford-bornrapperTrade markBlud,specificallyforthisshow.















Therewillbetwoshowingsofthe eventonWednesday,December21,one at5pmandthesecondat9pm.
Theeventisfreetoattend,buttick etsmustbepre-bookedinadvanceas therewillbenoentrywithoutaticket Telfordresidentsarebeinggivenprior itybookingforwhatisexpectedtobea verypopularevent





























Residentslivinginthe Telford& Wrekinboroughwillhavepriorityac cesstobookinguntil10amThursday, December 15,after whichtimethe bookinglinkwillbeopenforall.

Thebookinglinkwillbeavailable ontheTelford&WrekinCouncilFace bookpage@TelfordWrekin



Celebrating
Aspokesmansaid:“Telford&Wre kinCouncil commissionedCelestial, adrone artcompany, to create the 15-minuteshowcelebratingallthatis Telfordaswellaslocalartist Trade mark Bludtowrite andproducethe soundtracktoaccompanytheshow

“Theresultwill be avisualfeast thatwillhighlightthelandmarksand eventsthathavemadeTelfordandWre kintheboroughitistoday

“Thestoryspansthehistoryofthe regionaswellasreferencingfeatures thatarerelevantandrecognisableto alltoday




“Theshowpromises to deliver somethingforallagesandasharedex perienceintherun-uptoChristmas.”
TrademarkBludisalocalmusician bornandbredinTelford,amulti-award winningrapperandwellknownforan electricliveperformance.Earlierthis yearhewasgreetedwitharapturous welcomewhenhetooktothestageat TelfordBalloon Fiesta as part of the ShropshireMusicAwardsline-up


This eventisbrought to you by Telford&WrekinCouncil as part of theeventsprogramme,providing a calendarofeventsand activities for residentsandtoattractvisitorstothe region
Telford&WrekinCouncil lead er,Councillor ShaunDavies(Labour) said:“This newevent will really be somethingforalltolookforwardto,a fantasticlightshowandaccompanying soundtrackthatwillresonateIamsure withsomanyofourresidentsasthey hearshout-outsofthemanylandmarks andeventsthatmakeupourborough.

“Iamdelightedtobebringingthis eventtoTelfordandWrekinandatthis specialtimeofyear,it’smoreimpor tantthaneverforfamiliestobeable toenjoytimeouttogetherandsharing festiveexperiences


“Wewantyoutoenjoythisevent asmuchaspossiblesopleasedressap propriatelyfortheweatherandcondi tionsandensurethatyouhaveaticket bookedtoattendtheevent


“Welookforward to seeing you there!”

Festivefundraising day forAlzheimer’scharity

Staffatatowncouncilchannelled theirinnerBuddyanddressedupas elvestoraisemoneyforanimportant cause.
NewportTownCouncildecidedto dressupaselvesforElfDay,aninitia tiveledbytheAlzheimer’sSociety

Councilmembersdonnedtheir elvishcostumeslastweek,takingpic tureswithmembersofthepublicwho donatedtothecause
Aspokespersonforthecouncilsaid: “Todayourstaffdressedupaselvesfor ElfDaytoraiseawarenessandmoney fortheAlzheimer’sSociety

“NewportTownCouncilisademen tia-friendlycouncil,andproudtobea memberoftheNewportDementiaAc tionAllianceandiscommittedtohelp
ingpeopleinourcommunitywhoare affectedbydementia
“Manyofourstaffhavefirst-hand experienceofcaringforsomeonewith dementia,sothisisacauseclosetoour hearts
“Pleasesupportthisworthycause.”
TheAlzheimer’sSocietysaysthat £10raisedforthecharityprovidesthe firstconversationwithoneoftheirex pert dementia advisers,which turns four ordinary citizens into so-called superherodementiafriends.
And£50 raised forthe charity means312peoplecanaccesstheirhelp fulonlinecommunity,TalkingPoint.To donatetotheAlzheimer’sSociety,call 03303330804orgotoalzheimers.org. uk/get-involved/make-a-donation
58 MoonshineandFugglesis afamilyrunbusinessbased inpicturesqueIronbridge, Shropshire. Foundedona‘TrueLove’of Gin,Whisky,RumandLocal Alesalongwithotherspirits andalcoholicdrinks. Weaimtoprovideyouwith trulyexcellentserviceand greatproductchoice. 6TheSquare,Ironbridge,Shropshire,TF87AQ 01952433626 |www.moonshineandfuggles.com @moonshineandfuggles |@moonshineandfuggles ACHRISTMAS DRONE SHOW 21 DECEMBER 2022,QEII ARENA Brought to you by Telford &Wrekin Culture and Events Team SpecialistGrills &Indian Curries HAPPY HOUR Mon& Tues All DayWed -Fri 12pm -4pm Carling, Strongbow& Worthington’s SERVING FROM 12PM, 7DAYSA WEEK Hop &Vine, High St,Hadley,TelfordTF1 5NG 01952 261596 www.hopandvine.co.uk £3 APINT * *T’s &C’s Apply Book now forChristmas / Office Party’s CHRISTMAS 11
show
puts town in spotlight
MusicianTrademarkBlud
Basicqueue theoryis what the NHSdesperately needs
Forvarious reasonsIhave madevisitstohospitalswhichin cludedlongwaitsinambulances, hospitals,doctors’surgeries,and soon
Thewhole business seemed monumentallyinefficient.Isawno signsofbasic“queuetheory”use “Queue theory”providesarich andusefulset of mathematical modelsfortheanalysisanddesign ofserviceprocessfordealingwith
contentionforlimitedresources


Have you noticedhow bank queues aremuchshorterthan theyusedtobe,asaresupermar ketqueues?Asyouwaitforabank or supermarketqueue to clear youwillnotwaitverylong.That’s queuetheoryworking






Have you waited in an am bulanceoutsideA&Eorwaiteda monthtoseeadoctor?Idonotsee thesequeuesshiftingwiththeuse
Resentment over pensiontriplelock
Thereseems to be acertain amountofresentmentinsomesectionsofourcommunitiesregardingthe statepension triplelock guarantee.
Letmeclarifyafewareas.
1) Although thetriplelock pensionguaranteewasoneofthe Conservatives’manifestopromis es,itwasn’tpaidlastyeardueto the£70billionpaidintothefur loughscheme.Idon’tknowmany pensionerswhohadfurloughpayments,perhapsrecipientsshould paythatbacksopensioners can havewhattheywerepromised?
2)Nextyear,mostpensioners willhavea£14aweekrise.Bythe timetheincreasedtaxonanyoth er earnings hasbeenpaid, most


willonlybe£11.20aweekbetter off.
3)It’ssaidifyou’vegotapri vate pension youdon’t need the rise.Unlikethe tax andNIpay mentswe’vemadethathelpsfund thestatepension,privatepension contributionsweren’tcompulsory Youshouldnotbepenalisedfordecidingtoinvestinyourretirement
4)It’sassumedthatourgenerationhaditeasyastherewasplentyofjobsabout.Jobswerethere, butnotalwaysthejobsyouwant ed, you took thebestavailable Therearemorethanonemillion unemployedintheUKandthere aremorethanamillionvacancies
Nameandaddress supplied
ofrelevantalgorithms.Imaybe wrongandifIam,thenstartagain NHSbecauseyouhavenotaclue abouteventhemostbasicuseof mathematicalanalysis
Ilookforward to thedays when medial queuesare shifted seamlesslybyclinicaldemandand notbytradeunion“negotiation”as theyseemtoberightnow

RobinLloyd,Shropshire
Living with less money
Don’tthe workers whoare striking realisethatthere are many wholiveonfar lower in comesthantheyhave,andthatif wagedemandsaremet,thenpricesandcostswillsimplyincrease?
Ifyoustandatasupermarket checkout andsee theunneces saryandexpensiveitemspeople buy;crisps,tinymorselsofready meals, andprettytinsofbeans costingthreetimesasmuchasthe ownbrandthenyourealisethat mostshopperscouldliveonhalf thewagesquitecomfortably
Also charities– allbegging formoremoney,foroverseasaid, tigerrescue,donkeys,apes,catrehoming.Bettertogiveapoundor sotoabeggarinthestreet

Better worldwas alla dream
Onenight as Ilay dreaming during thehot,dry period,my dreamcametrue.
1.Thatwatercompanieswould seewhatwasneededandactim mediatelytoinvestandcombatthe longperiodofneglect.Theywould joinwithothercompaniestoensurethattheUKhadthebestfacilitiesinthedevelopedcountries.

2. They broughtinexperts frommanyfieldsandskilledwork

erstoensurethatall pipework supplyoffresh,and disposal of pollutedandcontaminatedwater wouldnotleak,toensureourtaps always gave freshwater andno wastefloodedorleakedtopollute ourhomes,streets,naturalwater suppliesorseas.

3. Wasteofrainfallwas stoppedbycreatingstorageareas belowgroundatfrequentinter vals,sothewaterstoredcouldbe

fedaftercleaning,intoourfresh watersupply
4.OurWatercompaniesused cheaperwaysofdisposingofour wastewatertogointoourwater supply
5. More employment,asafer environment,moreenjoyment, a betterworldforall.
ThenIwokeup.
BrendaFlowers,Shropshire
�� ����� ��� �������� ����������� ���� ��������� ���� ��������� �������� ��������������������������� ���� ����� ���� ������� ���������� �������� ��������� ��� ����� ����������� ���� �������� ��������� ��� ������ ��������� ������ ������ ����������� ������ ������ ���� ��������� �� ������������ ���� ������ �������������������������������� ���� �� �������� ������������������� ������ �� ��� ����� ������ ��� ��������� ���������������� ������ ������� ����� ������ ������ �������������� ������������ ������������������ ���������� ��� ��������� ��������� ������� �� ������ ����������������������� ����� ��������������� �������� ������� �� ���� �� ��������������� ������������ �������� ������������� ���� ������������ ������� ������ ��������������������������� ��������� ����� �������������� ������ ��������� ����� �������������� ������� ���� ������ ��������� ��������� ����� ����������� ����������������� ��������� �������� ��������� ������ �� ���� ���������� ���������� �������������������������� ���� ���� �� �������� ���� ������� ������� �������� �� ���� ������ ���� ��������� ���� �������� ���� ������� ������ ���� �������� ���� ������� ������� ������� Find us at Waterloo House, CastleTerrace Bridgnorth, WV164AH Call: 01746 763650 SoftToys•BabyToys•Toddler ToysPuzzlesforallages•Lego Vehicles•Playmobil•Jellycats Bigjigs•Bruder•Siku•Barbie L.O.LDolls•OrchardGames RainbowHigh•Airfix ThomasandFriends•Puppets Melissa&Doug•Marvel&DC HarryPotter•Board&CardGames FisherPrice•Vtech EducationalToys &MANYMORE! Monday-Friday 9:30am-5pm Saturday 9:30am-5pm Sunday 11:30pm-3.30pm Click &Collect Available. Local Delivery on LargeItems. MERRY CHRISTMAS! alleykatztoyshop.co.uk alle ykat zt oy shop .c o. uk alle ykat zt oy shop .c o. uk alle ykat zt oy shop .c o. uk alle ykat zt oy shop .c o. uk alle ykat zt oy shop .c o. uk alle ykat zt oy shop .c o. uk alleykatztoyshop.co.uk Visit: bookanad.shropshirestar.co.uk Make money quick, just upload apic!
Nameandaddresssupplied
LETTERS TELFORDJOURNAL | THURSDAY, DECEMBER 8, 2022 12 Code of Practice: Our policy is to correct errors as soon as we can. The Journal adheres to the Editors’ Code of Practice, which can be seen at www. ipso.co.uk. If you areunhappywith the accuracy of astory, write to The Editor, TelfordJournal, Midland News Association, 51-53 Queen Street, Wolverhampton, WV1 1ES. If we cannot reach aresolution contact Ipso at complaints@ipso.co.uk or by post at Ipso, c/o Gate House, 1Farringdon Street, London, EC4M 7LG GETINTOUCH By email: daniel.morris@mnamedia.co.uk By post: Readers’ letters Midland News Association 51-53 Queen Street Wolverhampton WV1 1ES Letters must include afull name and address. The Editor reserves the right to condense letters. Distribution Areyou experiencing delivery problems with the TelfordJournal? Get in touch with our customer service team today. Email: ssstarservice@shropshirestar.co.uk. Please include your name, address, postcode and contact number or call freephone 0800 146540 Monday to Friday 10am to 4pm (Callback service available).
Dobby
With Dogs Trust






Name:Dobby Age:4 Breed: Rhodesian Ridgeback Cross

Dobbyisabeautifulboywhothe team have nicknamedBFGB–Big FriendlyGoodBoy!Heloveslifeand greetseverydaywiththeenthusiasm ofapuppy



Helovesbeingoutdoorssowould likeownerswhoenjoyheadingouton walksandadventuresasmuchashe does,particularlyexploringfieldsand woods.Heloveshistastytreatsand worksreallyhardathistraininginre turnforone,ortwo!Heisveryplayful,








likesasofttoyandlovesagameoftug




Duetohimbeingaboisterous,big boy, Dobbywould best be suited to an adult-only home,preferablywith ownerswhoareusedtolookingafter bigger,livelydogs.Hewouldpreferto bewalkedinquieterareasashereacts tootherdogsandsohecanrelaxin hisgardenhewillneedtolivesome wherewithoutneighbouringdogs.He willneedtallfencingtoo,preferably sixfoot,sothat,givenhisadventurous nature,hecan’theadoffonadaytrip onhisown.
If you canoffer Dobbya loving home,andarewillingtocarryonwith funtrainingsessionswithhim,please gotowww.dogstrust.org.uk

Dental Implant Treatment Contact our team to book aconsultation Respected throughout the dentalindustry in theUKand Europe, Jason Buglass has been providing implant dentistry since 1993 and hassuccessfully placed thousandsofimplants. Patientsrequiring implant treatment canbookdirect at Oracle Shrewsbury to be treated by Jason without the need to leave your regular dentist. During theinitial consultation you’ll be advised on thebest treatment options availableand you’ll also receivea patient pack detailing everything that’s involvedthroughout your implant journey. 01743 466 796 info@oracledental.co.uk|www.oracledental.co.uk 10 LongbowClose |Harlescott Lane |Shrewsbury |SY1 3GZ by Jason Buglass GDC. Number: 61834 ith ludi no “comf USE YOUR LOFT Access your loft safely and easily with Bison loft stairs. A“gas” strut mechanism requiring just fingertip control makes opening and closing your loft stairs exceptionally easy •Fully manufactured by us in the Midlands •Free Survey •‘Bison’ loft ladders, only available from us •Full 5year parts & labour guarantee •The onlyproduct available with a safety handle in the loft •Fitted in approx 2hours (including making the opening larger) • NEW:Now available in white no painting required* • NEW:Now complete with “comfort” feet to protectcarpets and wooden floors. NEW:Long SafetySide Handles We also fit loft flooring, lighting and roof windows. Over 15,000 Installations Safety hand rail Unique to Bison Price includes twohandles inside the loft &one side handle £450 Specialofferfor limitedtime £335 (inclVAT) QuoteRefXX Price includes twohandles inside the loft and one side handle www.bisonloftladders.co.uk The Loft Stairs Company, Unit 60, Atcham Industrial Estate, ShrewsburySY4 4UG Freephone 0800 389 1281 or mobile friendly 01743 761499 *At extracost. All major credit cards accepted Access your loft safely and easily with Bison loft stairs. AHydraulic strut mechanism requiring just fingertip control makes opening and closing your loft stairs exceptionally easy •Fully manufactured by us in the Midlands •Free Survey •‘Bison’ loft ladders, only available from us •Full 5year parts &labour guarantee • The only product available with a safety handle in the loft •Fitted in approx 2hours (including making the opening larger) • NEW:Now available in white no painting required* • NEW:Now complete with “comfort” feet to protect carpets and wooden floors. •Price is for afitted unit up to 24 inch es wide and in aplaster board ceiling £450 Special offer for limited time £365 (inclVAT) Quote Ref XX Over 20,000 Installations The Loft Stairs Company,Unit 60,Atcham Industrial Estate,ShrewsburySY4 4UG Freephone 0800 389 1281 or 01743 761499 *At extra cost.All major credit cards accepted Make money quick, just upload apic! Visit: bookanad.shropshirestar.co.uk FEATURE THURSDAY,DECEMBER8, 2022 | TELFORD JOURNAL 13 HARLEY
is aspringer spanieland his
is abluemerle
Owner Rosemarie Dicks saysher eight-month-oldsproodle Harley is ‘beautiful,very fluffy and friendly’.His mother
father
poodle. “Heloves to play withmygrandchildren Ryleyand Raigen,”said Rosemarie.Keepsending yourpet picturesto daniel.morris@mnamedia.co.uk
Covid-19 and fluspread more easilyinwinterandcancause seriousillness.Sothebestway tostaysafeistoboostyourim munitywithvaccination.Ifyou’re50or over,pregnant,orhavealong-termcondition you’re eligible foranautumn Covidboosterandfreefluvaccination
“FluandCovid-19areunpredictable butthere arestrong indicationswe couldbefacingthethreatofwidelycir culatingflu,lowerlevelsofnaturalimmunityduetolessexposureoverthe last twowinters,and an increase in Covid-19 circulatingwith lots of variantsthatcanevadetheimmune response,”saysDrSusan Hopkins, chiefmedicaladvisoratUKHSA.“This combinationposes aseriousriskto ourhealth,particularlythoseinhigh riskgroups.TheH3N2flustraincan causeparticularlysevereillness.Ifyou areelderlyorvulnerablebecause of otherconditionsyou areatgreater risk,sogettingthefluvaccineisasensible,potentiallylife-savingthingtodo.
Weareextremelyfortunatetohave vaccinesagainst thesetwo diseases. Most eligiblegroupshavebeenselectedbecausetheyareathigherrisk ofsevereillness.”

Manyadultsand childrenalready getafreefluvaccination,whichisimportanttokeepuptodateasthevirus canchangeeachyear(findoutifyou’re eligibleatnhs.uk/wintervaccinations) Similartoprimary school aged children,two-andthree-year-oldsareeligibleforanasalsprayfluvaccination, providedtheywereagedtwoorthree on August 31, 2022. They gettheflu vaccineattheirGP.Primaryschoolkids usuallyhavethevaccineatschool.
Best protection
ProfessorSteve Powis,NHS England nationalmedicaldirector,warnsofa possible‘twindemic’ofCovidandflu, butsaysvaccinesofferthebestprotectionagainstit.“Withmanypeoplein hospitalwithCovid-19,andfluposing anevengreaterriskthisyear,Iurge everyone eligible to book both vac cines as soonaspossibletoprotect themselvesandtheirlovedones.With thousandsofGPpractices,localphar maciesandotherNHSsitesacrossthe countryofferingbothvaccines,it’snever beeneasiertogetthisprotection.”
Remember,ifyou’reinan eligible groupandnothadyourfirstorsecond dose of theCovid vaccine, or first boosterdose–bookanappointment onlineorvisitawalk-incentre
Mum of two Nicole,41, has lived with ulcerativecolitis since she wasin her20s and, likemanyotherswith aweakenedimmune system, she says keeping up to date with her Covid and flu vaccinations is vital.


“Ulcerativecolitis causes inflammation of the colon,and if I have aflare-up Ican getquitepoorly,with bleeding anda need to go to the toilet around 30 timesa day, which canresult in hospital stays,” says Nicole,fromManchester,mum to Sofia, six, and Alyssia, two.“No one canlivelikethat, so Ihave regular doses of immunosuppressants
“Running my baby sleep coaching business Baby2Sleep,and having twolittle kids,there’s no wayIcan function when I’mpoorly.”

Nicole waswaiting foramessage
–and when she wasalso offered the flu vaccine nthe same day, she as glad to take both.
“With my weakened mmune system, Iwas orelievedtoget my accinations.Ialways makesureI’m up to ateand have aflu ab every year.
“I wasworried hat if Icaught Covid I might endupin hospital,unableto ookafter thekids.”

Nicole is glad she canlivelifeto thefull, knowing she’s protected.


“It’s true that the vaccine doesn’t alwaysstopyou getting Covid, but it doesstopyou getting very ill with it, which is what’s importanttome. To dateIhave had Covid twiceafter my vaccinations and been fine.”
Whyisitimportant
Asatype1diabetic,I’m fullyawarethatthepotential sideeffectsofcontracting flu,coldsorCovidcanbe moresevereandcanplay havocwithmybloodsugar levels.Assomeonewhois immunocompromisedand whohasexperiencedthese sideeffectsinthepast,and withmyworkschedule presentingshowsandshoots alloverthecountryduring thePremierLeagueseason andupcomingWorldCup, Idon’twanttotakeanyrisks thiswinter
Did your diabetes diagnosis come as ashock to you? WhenIwasfirstdiagnosedin 2015,itwas atotal shockto
me,andIkeptitto myselfand close family andfriends foracoupleof years.Ididn’thave anyongoinghealth issuesandhadfull bloodstaken six months prior to di

THECOVID-19BOOSTER ANDFLU VACCINATIONS ARETHE BEST WAYTOPROTECT YOURSELF THIS WINTER –ESPECIALLYIF YOULIVEWITHALONG-TERMILLNESS. GRAB THOSEJABSNOW
‘I don’t want to take any risks thiswinter’
to you to have your Covidand flu vaccinations?
SkySports presenter Adam Smith, 37,was shocked by his diabetes diagnosis –but it’s encouragedhim to be extra-careful whenthere areviruses about
Nicole Ratcliffe lives with along-term condition –but needs to stay healthytolook afterher daughtersand run abusiness
from her GPtocall her forthe Covid vaccine
THE COVID 19 BOOSTER AND FLU VACCINA
getyour Covidand
f of on wa im so va m da ja t m h lo ‘With my weakened immune system Iwas glad of the vaccine’ I’maware that thepotential side effectsof contracting flu, coldsor Covidcan be more severe
Staysafe:
flujabs
for somethingcompletelydifferent, which showednothingamiss Thatchangedreally rapidlywithinafewmonthswhen ybecameveryill–I ustedand losing witharagingthirst stantneedtogo
ureact to thenews? challengingtoget round. I’dbeenin beforefor minor eeverythinggets youleave.Notthis as told:“Youhave pe1diabetesand willneedtoinject insulinevery day.”Howoften? “Fivetimes a day.”For how long?” Forthe restofyourlife Ifyoudon’t,you won’tsurvive.”
So it’s even more vital youhave the vaccinations? Yes! Ipersonally don’twanttotake chances,which is whyIwillbegetting Covidandfluvaccisthiswinter.
London-based business development director BayanMohajeri, 26,has multiple sclerosis,which makes him vulnerable to infection –sovaccinesare

“Duringthe pandemic I’dbeen isolating along with my mother, whois also immunocompromised. My neurologistput me forward foranew treatment called HSCT –it’sa week of intense chemo in an isolation room
“Theycollect your stem cells, freeze them, then wipeout your immune system completely and giveyou the stem cells back to create anew immunesystemin you. It meant my immunesystemwas pretty much that of anewborn “I then spentamonth in a hospitalroom. When doctors enteredtheywould be fully masked-up and my room was
disinfected everyday as I wassovulnerable.
“After 100 days Icould start gettingrevaccinated– all my childhoodjabs, thefluvaccine and my first Covid vaccine earlier his year
“That wasa hugemilestone –I wasnow on a ourneybackto normallife’.
“I had to have three Covid doses, then Iwas able to move back to London anddo things –thoughI still stayed outdoorsjusttobe safe.Ihad abooster inAugust, then another booster about three weeksago.It’svital to do everything Ican to protect myself.The colder it gets,the
vitalfor him

moreyou’restuck indoorswith an increased risk –especially with immunitywaning over time –soitwas critical Igot thelatest Covidjab andthe flu vaccine.

“It means Ican do regular activities: I’mgoingona work trip abroad, andifitwasn’tfor the newbooster,I’m notsure Iwould have been going.”

‘Vaccinations help me lead anormal life’
As it gets colderthe risk increases–so it wascritical Igot theCovid boosterand fluvaccine Thenumber of people in the UK whohave received at leastone Covid vaccine to date v t h j ‘ t t t 54 MILLION YOU ARE 65% 90% Covid boostersand free fluvaccinations areavailable forpeople with certain long-term healthconditions less likely to be hospitalised with Covid-19ifyou are vaccinated and have had abooster dose in thelastsix months Aftersix months,the effectiveness of the Covid vaccine drops from about 85%to60% Within 14 days of receivingyourCovid booster,your immunity againstserious illness will be increased to about 90%
catchCovid and haven’t hadthe vaccine aremore
to givebirth prematurely– and
risk
their
Pregnantwomenwho
likely
there’s ahigher
of
baby being stillborn
seriousillness.Tofindoutifyouareeligibleandbookyour appointmentvisitnhs.uk/wintervaccinations
CROSSTALK
With Reg Wilford
Thereisastateofanticipationin myfamilyasmygrand-daughteris abouttohaveababyboy
Preparationsare well in hand andthe local maternityunitwell awarethatthebirthisimminent.I haveeveryconfidencethatshewill be well looked afterbyqualified midwives,who will ensure sheis giveneverybitofhelpfuladviceand careinacleanandsafeenvironment
WithChristmasaroundthecorner,IreflectthatMaryandJoseph hadnosuchwellorganised plans. TheyturnedupinBethlehemfora Census with nowhere to stay, fin ishedupinanareaprovidedforan imalswhereJesuswasbornandlaid inabedofstraw.Wedon’tevenknow iftherewasalocalmidwifeavailable tohelpthem
It wouldhavebeenastressful timeforMary(andJoseph)butalso oneofjoyandthanksgiving.Ifyou arefacingfinancialstressdon’tlet Christmasmakeitworse.UseChrist masasatimetorelaxinthecompanyoffriendsandfamilybygetting agreementtokeepitsimpleandletit beajoyfulday
Cherishedpopular pets
ONTHEWILDSIDE
By Ben Waddams
Foraspecieswhichisnon-native andinvasiveandwhichalsoeatsits owndroppings, rabbits arerather popular.
Thethird most cherishedpet apparentlyandalongwithsquirrels andrats,probablythewildmammal youaremostlikelytosee.
Butasidesfromtheirfluffyap pearanceandappealinglooks,what isthestorybehindtheirnaturalhis tory?Wehavehadagoodchanceto gettoknowthemastheyhavebeen hereforaverylongtime.It’sthought theyarrivednotlongaftertheNor manConquestin1066.Theywere initiallyspreadthroughoutEurope fromtheIberianPeninsularbythe Romans,althoughtheyappearnotto havereachedBritainuntil700years aftertheRomansleft
Rabbitsweredomesticatedfor meatintheearlymiddleagesand werekeptinextensivewalledenclo surescalledwarrens.AtoneChrist masfeastinthemid1200sheldby HenryIII,500haresand200rabbits were eaten. Theirmainpredators are foxes, weasels, stoats,polecats andbirdsofprey,specificallybuz

zardsandgoldeneaglesinScotland. Thisisaverygoodreasonfortheir habitof‘refection’.Inordertogetfull nutritionalvalueoutofitsgrassand herbfood,arabbitorharemustpass itthroughitssystemtwice,eatingits owndroppings.Butapartfromthe nutritionalvalueofdoingthis,italso meansthattheanimalsspendless timeoutintheopengrazingandcan
dosomeoftheirsecondary‘eating’ insafehideaways,hiddenfromthose aforementionedpredators. We allknowwhattolookfor whenscanningthecountrysidefor thisspecies,beittheanimalitselfor theirpilesofdroppings,footprintsin thesnoworwarrenentrances.But lesswell-knownarethesoundsthat rabbitscanmake.Althoughrelative
lyquiet,itdoeshaveatleasttwovocalisations.Thebest-knownisahigh treble scream or squeal.Thisdis tresscallhasbeenlikenedtothecry ofapiglet.Duringthespring,bucks express contentment by emitting gruntingsounds.
n Ben’snew paintingsare on showinCallaghan’sandRowlesGallery,Shropshire.
Festiveshoppers to rein in thespending


Almosthalfofconsumerssaythey plantocutbackonfestivespendingthis yearasanestimated2.2millionhouse holdsdefaultedonavitalpayment.
Some46percentofconsumersare cuttingbackthisChristmasduetothe risingcostofliving,Which?found,with 41percentplanningtobuyfewergifts, 30percentsayingtheywillbuycheaper orlessfoodanddrinkand23percent planningtostayathomemoretosave money.

Evenamongthe8percentofpeople whosaidtheywouldbespendingmore, thiswasdriveninmanycasesbyprice increases.
Which?’sconsumerinsighttracker alsoshowedanestimated2.2million householdsmissedordefaulted on a vitalpaymentsuchasamortgage,rent, creditcardorbillpaymentinthelast

month,upfrom1.8millionlastNovem ber.Justundersixin10people(57per cent)madeatleastonefinancialadjust mentsuchascuttingbackonessentials, sellingitemsordippingintosavingsin thelastmonthtocoveressentialspend ing.
Thisisasignificantincreasefrom thealmosthalf(46percent)makingfi nancialadjustmentsthistimelastyear butlowerthanthepeakof65percent inSeptember
Some90percentareworriedabout energypricesand86percentarewor riedaboutfoodprices,84percentare concernedaboutfuelcostsand66per centabouthousingcosts.
Foreachconcern, theproportion worriedhasincreasedbymorethan10 percentagepointscomparedwiththis timelastyear

IsleofWightHouseParty_E.pdf SCARBOROUGH WHITBY&HISTORIC YORK Departing Mon 20 Feb‘23 Scarborough is the perfect destination forour five-daygetaway,belovedfor itspretty beaches, fabulous attractions, and classic charm! On this delightful break we enjoyafull excursion programme, which includes visits to the seaside town of Whitby and visit the historic city of York. Your breakincludes Return coach travel from Telford 4nights at aselected hotel in Scarborough with dinner &breakfast 2for 1bar (6pm-9pm) on selected drinks Entertainment everyevening Excursions to Goathland, Whitby& York Optional excursiontoBeverley(£7pp) 5Days by Coach only £149 Single Supplement £60 ISLE OF WIGHT HOUSE PARTY Departing Fri 10 Mar ‘23 Treatyourself to abreak away to the Isle of Wight with its dramatic whitecliffs and pretty resorts, and be prepared forfun and amusements by the bucket (and spade)load! There’salso afabulous drinks offer to enjoyatour hotel on this lovely short break. Your breakincludes Return coach travel and ferry crossings from Telford 3nights at the Holliers Hotel, Shanklin with dinner &breakfast Happyhour beforedinner every evening Entertainment some evenings ExcursiontoNewport &Ryde Optional excursion to Cowes, Yarmouth &Ventnor (£12pp) 4Days by Coach only £199 Single Supplement £45 in association with Formoreinformation or to book, please call: or visit online at: 033numbersare free within inclusiveminutes packages otherwise standardratesapply Operated by JustGoHol days Ltd. Coach package holidays and short breaks aresubject to JustGo! Holidays termsand conditions.Your booking is protectedbyBonded Coach Holidays (BCH) and the Association of Bonded Travel OrganisersTrustLimited (ABTOT); this is agovernmentapprovedconsumer protection scheme. Toursoffered subjecttoavailabil ty and governmentguidelines. Errorsand omissions excepted. Prices perperson, based on twopeople sharing adouble/twin room. Calls to 033numbersare free within inclusiveminutes packages otherwise standardrates apply 03332 342 529 justgoholidays.com/WOL Quote WOL TelfordJournalSeries Your weekly newspaper AJ351756_v5_56
FEATURES TELFORDJOURNAL | THURSDAY, DECEMBER 8, 2022 16
Rabbitshave been partof Britain’s wildlife for avery long time
Keep it simple, keep it joyful
Some46percentof consumersarecutting backthisChristmas
By Sam Wylie-Harris
LookingforChristmasshopping inspiration?Prettymucheveryone lovessomethingnewforthehome andtheoptionsareendless Whetherit’sanartisan piece toaddinterest,anexcitingkitchen gadget or glitzy deco you’dnever splashoutonyourselfbutwouldlove toreceive,homegiftscantakeohso manyforms.



Andtohelpyoubeatthecrowds, we’veplucked thebestpresents fromthepile…


1. RussellHobbsRHMD714BL 17L700WScandibluedigitalmi crowave,£84.99,Amazon


Microwaves arehavingamoment–usingasoupçonofaconventionaloven’senergy–andthisone’s especiallysought-after.Welovethe attractive Scandi-style,plusitfea tureseight auto cook menus, five powerlevelsandmulti-stagecooking.


2. Pomegranatepillar candle, £22,TheWhiteCompany

Ifyouscentsurroundwithonly onecandlethisChristmas,theentic ingexotictopnotesofpomegranate,




















muskypatchouliandtouchofamber alwaysfeelsrichandfestive.
4. I’mDreamingOfAWine

Christmasreversiblecushion, £45,Neonimo

This soft,velvet-feel cushion is sealedwithaheartzippendant.One forthewineloverinyourlife

Everycheeseboardcriesoutfor therightknifetosliceintoacorner ofStiltonorripebrie.Presentedin agiftbox,thisrattan-handledsetis tailor-madeforseasonalsettings

ISYOURPROPERTYLEAKINGINCOLDAIR? •Doyou feel your home or business is colder than it should be? •Can’t quite detect wherethat cold draftiscoming from? •Find it hardtokeep certain rooms or partofthe building warm? Consider aheat loss survey using an infraredcamerawhich detects small temperature differenceswithin thebuilding to help diagnose anypossible issues, from missing, inadequateorbadlyinstalled loftorcavitywall insulation, to drafts caused by small unseen gaps or cracks around windows, doors or roofs creating air leaks, which consequently means your heating system is working harder than it should be, by having to heat thecold air which is leaking into your property from the outside. CALL HEAT LOSS SURVEYS ON 07884849100 Check out our website WWW.MIDLANDSHEATLOSSSURVEYS.COM Withever increasing fuel costs –wecan save youmoney and help the environment too! Infra-red thermal cameras can also detect moisture, damp and water leaks from roofs, plumbing or underfloor heating issues and electrical circuit hotspots which areoften hidden from sight in walls and floors. Is your garden in need of amakeover? a makeover? ������������������ ��������������� �� ������������ ���� ��� �������������� �������������� ���� ��� ��� ��� ���� � �� ����������� �� �� ���� � �� ���� ��� � ����� ����� �� ���� ������� �� �� �� ���� �� �� ���� � ������� ���� ���� � ���� �� ������������ ����� ����������� ������� ������� �������� ������ ����� �������������������� ����������� �� �� ������ ��� ����� ������� ������ ������ ������ ������ ������� ������� �� ��������� �� ����� ������������������������ ���� ��� ��������������������� ����� ������ �� ��� ���� ������ � � ��� ��� � ��� WORKING FROM HOME? ARE YOU SITTING COMFORTABLY? If not visit our showroomfor awide range of office chairsondisplay Chrisbeon, Units B2 &B3, StaffordPark 4, TelfordTF3 3BA Tel: 01952 292606 Email: sales@chrisbeon.co.uk www.chrisbeon.co.uk To advertise in anyofour next features call Alison Jukes 01952 241339 Homes for Christmas HOMES THURSDAY,DECEMBER8, 2022 | TELFORD JOURNAL 17
forthe home thisChristmas
Treatyourselftosomething
5. Trinitygreen velvet round trinketbox small, £17.50;Trinity pinkvelvetjewelleryboxmedium, £29.50,and Trinitybluevelvet jewelleryboxlarge,£32.50,Oliver Bonas ‘Tistheseasonfortrinkets–and theseopulent velvet boxeswill do
Russell HobbsRHMD714BL17L 700WScandibluedigitalmicrowaveTrinityvelvet trinket boxesReversible cushion, Neonimo
Pomegranate
pillar candle afinejobofstoringthoseprecious piecesinstyle. 6. George grey bodyvase, £12, Direct.asda Bodyvases aretrendingbig time…surelythemostseductiveway to displaydried flowers andfresh blooms
7.AbigailAhernsetof3rattan handledcheeseknives,£35,Free mans
Howthe first 1,000 days have an impact on your baby

Hassocialmedia helped make self-improvement toxictrend?
IMYBRIGHTY-POTTS PressAssociation
TikTok is full of tips
us find new ways to be more produc tive,peaceful, efficient,
It’s longbeenknown that childhood sets alarge part of the blueprintfor therestofour lives. Butnew research suggests somethingevenmorespecific than that –events during our first1,000 days,fromconcep tion to agetwo,makeuswho we are.
Thenew book,WhatMakes aPerson: SecretsofOur First 1,000 Days,outlinessomesur prisingdiscoveriesthatshow what happensinthe period af terconceptionand birth, and explains howwecontrolour bodies throughprocesses that go waybeyondjustthe geneswe inherit.
So what arethe secretsof thoseveryearly days of life? Co-authors ProfessorMark Hansonand ProfessorLucy Greenshare afew of them
1. Foetuses ‘breathe’inthe womb –Hansonsaysthe latest informationsuggests foetuses make rapid,shallow breathing movements –althoughobvious ly they’renot taking anyair into theirlungs as they’resur roundedbyamniotic fluid.
2. Foetuses sleepand may dream –Green says research hasshown thefoetusgoes throughstatesofsleep,justas we do afterbirth, includinga statesimilar to dreaming
3. Early development in fluences risk of non-com municable diseases –The authorspoint outthatalmost three-quarters of deaths world wide arecausedbynon-commu nicablediseases (NCDs) such as heartdisease, stroke and cancer.Dutch studiesofchil dren born to women whowere near-starvationduringtheir Second WorldWar pregnancies have foundthatthose children whowerefamishedinearly ges tation hadasubstantially high er risk of many NCDs

4. Nutrient balanceeffects howgenes work –Hansonsays thebalance of nutrients, such as proteintocarbohydrate, af fectshow inheritedDNA works by epigenetic processes(small marksonthe DNA)which influ ence how theembryodevelops.
5. Thedigital worldaf fects youngchildren’s brain development –New research foundthatyoung children who spendseveral hoursa dayon screen-basedactivitiessuchas acomputerorTV show altered executivefunctions
and well-roundedevery time we switch on theapp. Self-helphashtags aregrowing in popularity #WorkOnYourself has119.5 million views, #GetYour LifeTogetherhas over 40 million and#SelfLoveLifestyle hasnearly threemillion.Itseems like every oneisscrolling forself-improve ment,and it’s made so much easier with seemingly countlessvideos at your fingertips –but thepressureto be better allthe time canget over whelming
Surely we can’tall be bettering ourselves allthe time?And at what pointdoesour desire to be better actually become aburden?
SOCIAL MEDIACAN MAKE US FEEL INFERIOR
When it comestoself-help,“Most of us want aquick fix–somebodyto tell us what to do andmakethings better”, suggests Gillian McMi chael, author andfounder of Full CircleGlobal(fullcircleglobal.com)
“Weare in an ageofsocialmedia overload –wecompare andcon trastourselves to others andwe want what they have.Never has therebeenatimelikenow,where keepingupwiththe Joneses hasa wholenew meaning. Socialmedia platformsshowcase how we canget ourgoals, change ourlivesand bet terourselves.But because it is in a short30-second clip,wedon’t know how to applythistoour ownlives.”
Andthisconstantbombardment of self-improvementcontent canbecome exhausting
“Withsocialfeedoverload, it is difficult to decide what toptips or ideasweshouldtakeonand do somethingwith, as thenextday therewillbethousands more reels
telling us to do somethingdifferent –it’sconfusing andunsustainable,” says McMichael. “Quick fixesnever workinany aspect of yourlife, espe ciallyyourwellbeing –Ithink this approach adds pressure andcan give false expectations.”
WE ONLY SEETHE BEST BITS
MaxHoveyisaninfluencer who focuses on empowering theLGBTQ+ communityand promoting body positivity andself-compassion
“The idea of beingyourperfect self hasalwaysbeenapressure from socialmedia,” he says,adding that ourobsession with self-improvementisthe “natural evolu tion”ofthis.
“Everyone hastheir ownstrug gle, andthe pressureconstantly to be ‘getting yourlifetogether’ is
incredibly toxic,”hesuggests.“The idea of ‘havingittogether’ doesn’t exist. I find it unlikelythatthe people creating thiscontent have it together anddon’t have otherstuff goingoninthe background
“Weare showingall thegreat things in life andnot showingany thingelsethatisgoing on,making otherpeoplefeelbad aboutthemselves.”
THEBUSINESS OF BEING PERFECT
Notall self-helponsocialmedia is toxic, with McMichaelsaying: “I thinkthere areahandfulofskilled professionalssharing theirtipsand techniqueswithawider audience Butthere arealot of people jump ingonthe bandwagon because well ness,self-improvementand trans formingyourlifeisinvogue now
morethanever.” In recent years, “The awarenessofmentalhealth hassignificantly grownand every onewants to better themselves,” McMichaelsays. “Hence, we are more informed,meaning these top icsare nowmorerelatable.”
However,McMichael recom mendsbettering yourself forthe rightreasons –and in asustainable way. “The realityissimple, you’d be much happierifyou invested in self-improvementand self-carebecauseyou wanted to find balance rather than theperfectionthatis presented
“Ifyou arelooking to change yourlife, then find aqualified coach to supportyou –ratherthansome body on TikTokwho is not qualified or experiencedenoughtogiveyou advice on whatyou should do.”
Change in routinecan help beat themorning blues
Waking up during thedarkerwin termorningscan become quitea challenge, as thelimited amount of sunshine cansignificantly impact thecircadian rhythm
Adapting thebedtime routine by having thelightsset to turn on automaticallytoaddingmoreVi taminB-12intothe diet canhelp people wake up feelingenergised forthe day. NicShacklock,from Online-Bedrooms.co.uk, shares eightusefultipstouse in yourbed time routinethiswinter:

n Make themostofthe day light– Walksthroughoutthe pre viousday canhelpnot only get enough VitaminD,but it will help keep youramountofcontact with

daylightatahealthy rate before theearly winter nightkicks in
n Turn lights on automatically –Setting thelightstoturn on at thetimeyou want to wake up,can make you feel morealert andready to getout of bed.
n Hottea in themorning Selectingthe righttea to drink is crucialtofeeling more relaxed andawake in theearly hours. Try greentea or peppermint tea
n Vitamin B-12 –Increasing theamountofVitamin B-12 in yourdietcan tremendously help to improve your energy levels and overallmood.Thiscan be done ei ther throughhealthy supplements or throughfoodssuchasapples,
oranges anddairy products
n Change your wake-up sound –Testingout different soundsfromrainfalltoocean wavescan help preventwakingup feelingsluggishbut rathermore peaceful andrelaxed
n Plan thenextday –Having theday plannedout canhelpyou feel motivatedwhenyou wake in thedarkermornings.
n Placealarmsaroundthe room –Place anotheralarm at the othersideofthe room so you have to getout of bedtoturnitoff
n Increase theroomtempat wake up time –Ifthe temperature is chillyitcan make you want to cosy up andstayinbed

forself-improvement, helping
self-compassionate
FAMILYLIFE TELFORDJOURNAL | THURSDAY, DECEMBER 8, 2022 18
Theconstant bombardmentofself-improvement contentonsocial mediaplatforms canbecome exhausting
Adaptyour bedtime routine
The first1,000 days arecrucial
Bake OffstarVal sharesher food budgeting tips
Householdbillsare aworry for everyone,but thereare stepsthat canbetaken to cutcosts on your food shopping whilestill making themeals you love
From discoveringdiscountsto prioritisingpurchases,former GreatBritishBakeOff contestant ValStoneshas shared hertop tips

n Is it aluxury or an essential? –Whentempted by apricey purchase, wait afew days before buying.You mayrealise theitem wassomethingyou wanted rather than needed –and you candevelop aplantosavefor it
n Skilluponcooking from scratch –Cookfromscratch (even
better with homegrownproduce) to save money; if you buyready meals, themaincostisn’t theingredients, it’s thepreparation that’s gone into making it.Planning mealsfor theweekahead can cutdowncosts as well as waste.
n Become ayellowlabel connoisseur –Bepreparedtoswitch tosupermarket home brands.I’m a lover of yellow discount labels,soI checkthe sell-bydates andwheth er they canbefrozen.
n Looksaren’teverything –Buying“wonky” vegetables doesn’taffecttaste,and they are oftensoldloose soyou aresaving on packaging.
n Be smartwithingredient choices –Pasta andricedishes areincredibly fillingand make use of low-costingredients– thereare lots of money-saving recipesavail able online andinmagazines
n Your freezerisyourbest friend –Iwill batchcookmeals that will serveenoughportionsfor multiple days,freezingthe lefto verstoheatuplater
n Turn to theinternetfor coupons –Learningtonavigate money-saving websites couldlead to huge discountsatthe supermar ket checkout –signing up to email newsletters oftenresults in discounts beingoffered too.
Cost of living crisis putting pressure on petloverstoo
VICKYSHAW PressAssociation
Pets areanimportant andmuch-lovedpartof thefamily– butfor some owners,the cost of their animal,ontop of other bills, is causingrealcon cern.
Research fordog welfarecharity
Dogs Trustfound more than four fifths (84%)ofdog owners have seen arise in costsrelated to theirpet Sadly, thecharity says itsrehom ingcentreshavebeenseeinga rise in dogs arriving with untreated health conditions.Itbelievesthis is duetosome owners simply being unable to afford treatment
“Weknowdog owners arefacing adifficult time,and eightin10dog owners have seen an increase in theamountitcosts to care fortheir canine companions,”saysPaula Boyden, veterinary director at Dogs Trust

“Manyare lookingat ways they canreducethe amount they are spending on theirdogs, butat Dogs Trust, we areworried that some of thechoices beingmadebyowners couldbedetrimental to thehealth of theirdog,and actually endup costingownersmoreinthe long term.”
Worryingly,one in 10 (10%)dog owners surveyed by thecharity haddelayedseeking treatment fornon-routine procedures dueto costs. Asimilar number (9%) had delayedormissed routineappoint ments. Thecharity emphasises it is notlayingthe blameatthe door of vets, whoare themselves impacted by rising costs.
Boyden says:“Whileskipping yourdog’s annual vaccinationsmay save you some moneyinthe shortterm,you couldbeputting yourdog at risk of seriousillness andeven death.
“Delayingboostersmay also re sult in theneedtorestart yourdog’s vaccinations, whichwill cost more.
“Wealsorecommend that you
keep up with your dog’s flea and worming treatments. Fleasmight seem aminor issuetodealwith, but abad infestationcan causeyourdog intense irritation.”
Delaying worming treatments is also arisk. Some types of worms areapublichealthriskand canbe passed on to humans,saysBoyden
As forfood costs, around in five (22%)dog owners surveyed by Dogs Trusthaveswitchedtheir usualdog food to acheaper version.
Forthose consideringdoing this, Boyden says it’s importanttocheck whetherthe food is “complete”and designed to be used by itself,or “complementary”,which needs to be served with otherfoodstodeliver alloftheir nutritional needs.
“It’salso reallyimportant to checkthe food is suitable foryour breedofdog andthe stageoflife yourdog is at,” sheadds.
“We’dreallyrecommend that dog owners speaktotheir veterinary surgeryfor advice before changing their dog’sfood to ensure it’s right fortheir pet, andtogradually in troduceany newbrand of food, as achangeindietcan cause stomach upsets.”
Senior vetDaveTweedle,who works forthe My FamilyVetsnet workofclinics, says estimatessug gest it cancostasmuchas£30,000 to keepa dogovertheir lifetime, and£24,000 foracat
He says asignificant proportion of dogs andcatsare actually overweight, whichcan lead to costly health conditions, such as arthritis, breathingproblems, heartdisease anddiabetes.
Keepingup-to-datewithparasite prevention,vaccinations, andget ting regular health checks canbe covered as part of monthlyhealth-
care plans, whichmanyvetsoffer, andmay provide valuefor money, he says
Meanwhile, theRSPCA’swebsite cautions that exotic petscan be particularly expensive. Thecharity warnsthatturning down temperaturesorlight sourcesfor exotic pets mayleadtoserious health problems forthem–and potentiallyhighvets’ bills.
It suggests that, forthose strugglingwithcosts, multiple reptiles couldbemovedtothe same room to shareheatsources –but make sure thatanimals do notoverheat
Petinsurance is also amajor considerationfor owners.The Dogs Trustfound 41%ofdog owners claimedthe cost of theirpet insurance hadincreased
Thecharity suggestsshopping around forcoverand always read ingpolicydocuments –asthere will be differencesinthe levellevel of cover,what’scovered andfor how long JonathanPurvis, at theABI, says:“TheUKpet insurancemar ket remainscompetitive despitethe underlying pressures insurers face, with therisingcostfor veterinary treatment,medicines andlabour
“Whenitcomestoour pets, thereis no NHSfor animalsand anyemergency treatment canbe eye-wateringlyexpensive,” he adds “Ifyou areconcerned aboutthe cost of your cover, speaktoyourinsur er to seeifthere areany optionsto manage this.You mayalso benefit from shopping around,but be sure to always chooseapolicythatbest suitsyourneeds.”
Graeme Trudgill,fromthe Brit ishInsurance Brokers’ Association (Biba),sayswithanew policy,it’s importanttocheck whetheritwill cover pre-existing or recurringcon ditions. “Accidentonly” policies will only cover treatment foraccidental injury
Trudgill adds:“Some cover is always better than none –and re member most petinsurancealsoincludes liability that cancoveryou if your petaccidentallyinjures some one throughnofault of yours.”
Howtoorganise your December social calendar andstayrelaxed
With thefestive season almost upon us,how canwestopourselves from burningout,but stillhavefriends left after? writes ImyBrighty-Potts December canbea blur of glitter, booze, familycatch-ups, partiesand secret Santas,which soundsgreat on paperbut in realityoftenends up beingextremely stressful.
But, saying no to invitations–particularly with theaddedpressure to make up forlosttimeafter lockdown –can come with abar rel-load of guilt. Youdon’t want to upsetanyone, butyou definitely can’tsay yestoeverything either
So,how canyou getthe best of both worldswithyoursocialcalendarinDecember?
n Theremay be alot ofpressure to seeeveryoneand join in with everything,but remember that you gettodecide what you sayyes to andhonouring yourlimitsis certainly nota badthing
As clinical psychologist Dr Mari anne Trent(goodthinkingpsychology.co.uk)says: “Itis ok if you have time offoverthe holidaystochoose rest andrecharge, insteadofadditional stressorsthatmay include socialobligations with friendsand familythatcan come with compli cationsaswellasjoy.Itisoktoset boundaries andprioritiseyourself.” n Gettingorganised couldhelp remove some of theoverwhelm Lizzie Grant, professional organiserand founderofDeclutter on Demand (declutterondemand.com), suggests:“Make alistofsocial events and‘must do by’deadlines you have coming up in December Forexample,booking theatre tick ets, restaurants andtravel.
“Thenadd theseevents to your digitalcalendar, with alerts with thecorrect date andtime. Include addresses forevents, so you’renot scrambling around trying to find thoselast-minute. Sync yourdigital calendar electronicallywithrelevant friendsand family,orprint out aphysicalcopyaswelland putitin thehallway or on thefridge where everyone in yourhousehold will see it.”
n It maysound over thetop, but feelingcalmand organisedmeans knowingwhere yourtimeisbeing spent. Time-blockingisagreat way to approach this –basically assign ingaset blockoftimeto each thing you need to do.“Putchunksof time in forsocialengagements and tasks, with astart and finish time, includinghow longitwill take you to getthere,” says Grant. “Thisenablesyou to seeexactly how much time you have availabletocommit to things otherthanthe festive pe riod.Remember,it’salwaysbetter to over-estimatethanunder-estimate how longthingswill take.”
Planning to only be at aparty foracoupleofhours before heading to somethingelse? Allowanextra hour at whichever one you would prefer to be at
n Stop committing to 1,000 things –and leavingnotimeorenergyfor thethingsyou trulylove alongthe way. “Identify what you most enjoydoing andwho you most enjoyseeingat this time of year,to make it special foryou,” says Grant.
Tackling petcarecosts canput pressure on struggling families
FAMILY LIFE 19 THURSDAY,DECEMBER 8, 2022 | TELFORD JOURNAL
Bake Off’sVal Stones
In the main, known to be useful to 6 (3)

Be generally in a hurry so a fight doesn’tget its proper time? (4,5)




HistoricYork&theDales_E.pdf ©M ar cel va nH oorn AndreRieu&JohannStraussOrchestraLiveinNottingham_E.pdf in association with OperatedbyJustGoHolidays Ltd. Coach package holidays and short breaksare subjecttoJustGo! Holidaysterms andconditions. Your booking is protectedbyBonded Coach Holidays(BCH) andthe Association of Bonded TravelOrganisers TrustLimited (ABTOT); this is agovernment approvedconsumer protection scheme.Toursofferedsubjectto availabilityand governmentguidelines.Errorsand omissionsexcepted. Prices per person, basedontwo peoplesharinga double/twin room. Calls to 033numbersare free withininclusiveminutespackages otherwise standardrates apply Formoreinformation or to book, please call: or visit us online at 033numbersare free within inclusive minutes packages otherwise standardrates apply TelfordJournalSeries Your weekly newspaper HISTORIC YORK &the Dales Departing Mon 27 Feb‘23 Joinusonthis lovely short break to beautifulYorkshire, where we combine therolling hills,panoramiclandscapesand charming towns of the Yorkshire Daleswiththe historic cityofYork. Don’t missout optional tripsto Knaresborough and Harrogate to complete ourdelightfully scenicgetaway Your breakincludes Return coachtravel from Telford 4nights at aselected hotel in the Leeds area with dinner &breakfast 2for 1bar (6pm-9pm) on selected drinks Excursions to York,SkiptonMarket& Grassington Optionalexcursion to Knaresborough &Harrogate (£11pp) 5Days by Coach only £149 Single Supplement £60 BOURNEMOUTH Weekend Departing Fri 10 Mar ‘23 Escape to the seaside andenjoy arelaxing weekend in Bournemouth, afantastic resortboastingseven miles of golden sands, ahistoric pierand magnificent gardens. From herewe visit Poolewithits nauticalatmosphereand the traditional resort of Swanage. Your breakincludes Return coachtravel from Telford 3nights at aselected hotelinBournemouthwithdinner &breakfast 2for 1bar (6pm-9pm)onselected drinks Excursion to Poole &Swanage Optional excursiontoDorchester &Weymouth (£12pp) 4Days by Coach only £159.99 Single Supplement £45 ANDRÉRIEU &his Johann Strauss Orchestra Departing Fri 14, Sat15Apr &Sat 24 Jun ‘23 Theclassical-music phenomenonAndré Rieu is returning to the UK in 2023, bringing hissensational newshowtothe M&S BankArena Liverpool, theResorts WorldArena in Birmingham and theOvo Arena Wembley in London! Your breakincludes Return coachtravel from Telford Overnight stay at aselected 3or4-star hotelwithbreakfast Ticket to André Rieu concert Return coachtransfers from thehotel to the venue En-routevisit to Liverpool, Birmingham or London Ticket upgrades available 2Days by Coach only £199 Single Supplement £35 Quote WOL justgoholidays.com/WOL 03332 342 529 PUZZLES TELFORDJOURNAL | THURSDAY, DECEMBER 8, 2022 20 Each number in the grid represents adifferent letter of the alphabet and every letter of the alphabet is used. Use the given letters to the right of the main grid to start you off. LAST WEEK’S SOLUTION: 1 6 5 4 8 4 2 7 8 3 4 6 7 6 9 7 8 2 2 5 4 6 1 4 3 7 4 5 9 6 2 1 Fillinthe grid above so that every column, every rowand each ofthe 3x3 boxes containsall the digits from 1 to 9. 9 5 6 7 1 8 3 4 2 7 2 4 5 9 1 8 6 3 4 6 3 8 2 9 1 7 5 3 6 1 8 4 9 5 27 4 8 7 2 6 5 9 3 1 1 7 5 3 9 4 2 68 1 9 2 6 8 7 4 53 8 7 3 1 5 6 2 9 4 5 3 7 9 4 8 6 2 1 LAST WEEK’S SOLUTIONS > 1 2 3 4 5 6 7 8 9 10 11 12 13 14 15 16 17 18 19 20 21 22 23 24 25 26 I E J H P Z Y D O V R N C F G L S U T X Q M A B K W 1 2 3 4 5 6 7 8 9 10 11 12 13 14 15 16 17 18 19 20 21 22 23 24 25 26 L O Across Down Quick Clues: 1. Sleepwalking (12) 7. Arrange (5) 8. Muscularity (5) 9. Choose (3) 10. Allusion (9) 11. Threaten (6) 12. Put in (6) 15. Overnice (9) 17. Conclusion (3) 18. Looking at (5) 19. Clemency (5) 21. The dumps (12) 1. Teacher (12) 2. Assistance (3) 3. Deprived (6) 4. Maze (9) 5. Blemish (5) 6. Obligation (12) 7. Frequently (5) 10. Oblong (9) 13. Foe (5) 14. Fate (6) 16. Combine (5) 20. Unburden (3) 12 345 6 78 910 11 12 13 14 15 16 17 18 19 20 21 LAST WEEK’S CROSSWORDSOLUTIONS: CRYPTIC –Across:4 Diverse; 8 Eyelet;9 Offhand; 10 Energy;11 Ill-use; 12 Severing;18 Putunder; 20 Fencer; 21 Ascent; 22 Reserve;23 Boasts; 24 Attends. Down: 1 Reverse;2 Deserve; 3 Beggar; 5 In flight; 6 Exhale; 7 Sanest;13 Improved; 14 Adverse; 15 Protest;16 Desert; 17 Scheme; 19 Upshot QUICK –Across:4 Capable; 8 Redeem; 9 Profane; 10 Virago; 11 Craven; 12 Disorder; 18 Powerful; 20 Career;21 Stolen;22 Achieve; 23 Precis; 24 Perfidy.Down: 1 Provide; 2 Address; 3 Beggar; 5 Airscrew; 6 Affray; 7 Linger; 13 Depraved; 14 Afflict; 15 Illness;16 Gauche;17 Relief;19 Extort. Across Down Cryptic Clues: Choose either quick or cryptic clues both fitthe same grid. 1. Not being bored, there’sprofitto
7.
8.
9. The
10. Trace
11.
12. Does
15.
17. It
18.
19.
21.
1.
2.
3.
4.
5.
6.
7.
10.
13.
14. Strand
16.
20. Dandy
Codeword Sudoku Double Crossword 1. What name is given to theact oftaking another person’swritings andpassing them offas one’sown? 2. Which Americanactor won aBestActor Oscar for Raging Bull? 3. What name is given to amusical composition for five instruments? 4. Who wrote The Cat in the Hat? 5. What sort of creatureisajacamar? 6. What name is given to aJapanesewoman whose traditional occupationistoentertain men? 7. Who was the first professional England cricketer to be knighted? 8. How many playersare thereinanice hockey team? 9. With which composer is the German city of Bayreuth associated? 10. How much isa‘double top’ worth in darts? Last week’ssolutions: Quiz: 1 Mary Quant; 2 Wyoming; 3 Gemini; 4 Gene Kelly; 5 Atlanta; 6 Eliot Ness; 7 Diamonds; 8 Rowan Atkinson; 9 Figure skating; 10 The Netherlands. Niner: FILAMENTS Each number from 1 to 9 represents adifferent letter.Solve the clues and insert the letters in the appropriate squares to discover awordwhich uses all nine letters. 1 2 3 4 5 6 7 8 9 1677242 gives amusical instrument 4358 gives amusical instrument 9385 gives amusical composition Niner Quiz BRAIN GYM No.717
add (4,8)
Frank left joint partly (5)
Impudence adds piquancy,itwould seem (5)
rubbish dump is mine when put back (3)
amop which may be taken to pieces (4,5)
Yes, rag is oily (6)
he hang around the bakery? (6)
Wherethe cobbler goes till he can go no longer? (2,3,4)
is put in by someone wanting arow (3)
Consumed in cafe at English resort (5)
This proposal can’tbeon (5)
Composing dissertation needed by 6 (7,5)
Co-operate, as Jacob did for Rachel (4,8)
She let ham become ruined (6)
One can easily get steamed up in it (5)
He is correspondingly active (6-6)
The fruit of temptation? (5)
Cuts when akernel is produced (6,3)
The speaker has it and dancers take it (5)
colour (6)
Coach of bad trout (5)
is a fathead at work (3)
Branagh’sin role of Poirot Square bids Dotfarewell

SATURDAY
Murder on the Orient Express (2017) (Channel 4, 9.15pm)
Thelittlegreycellsofmousta chioedsleuthHerculePoirotarerigorouslytestedinKennethBranagh’s handsomereimaginingofthesnowboundmurdermystery.Slippery gangsterSamuelRatchett(Johnny Depp)offerstopaytheBelgianto ensurehissafety.Thedetectivedeclines,butthenamurdererstrikes




SUNDAY
Casino Royale (2006) (ITV, 8pm)
DanielCraigbowedoutasJames BondinNoTimetoDie,buthere’s achancetoremember his debut. ThesecretagentisonthetrailofLe Chiffre(MadsMikkelsen),aninternational criminal planningtousea high-stakespoker gameas ameans offundingterroristorganisations. EvaGreenis007’s loveinterestVes perLynd

90shitmakers in test of musicknowledge


The Hit List (BBC1, 5.30pm, Saturday)

OnTheHitList,itprobablyhelps tohaveagoodbondwithyourteam mate,butisitpossibletoknoweach otheralittlebittoowell?




We could findout tonight, as MarvinandRochelleHumesintroducea1990sspecial.The contestantsareWestlife’sBrianMcFadden andBoyzone’sKeithDuffy,SClub7’s TinaBarrettandBradleyMcIntosh, and911’sLeeBrennan,pairedwith Sonia–andaccordingtothepresent ersit’sclearthatsomeofthemhave servedinthepoptrenchestogether

Marvinsays:“Youcantellthere wasalotofbanterflyingaboutbe tweenWestlife’sBrian McFadden andBoyzone’sKeithDuffywiththe SClubguysandLeefrom911,obviouslythey’vespentalotoftimeon theroadtogethersoIfeellike,as muchastheyloveseeingeachother again,therewasalotofbanter…”


Rochelle adds:“It seemed very friendly–itwasliketheywereback onthetourbustogetheragain.”

Inbetweenthebantering,they willbeansweringquestiononpop music,whichisthepointoftheshow Themarriedcouplearearguably theperfecthostsfortheshow–after alltheyhavebothabackgroundin pop.Rochellewasingirlgroupthe SaturdaysandMarvinfoundfamein


JLS.Rochellesays:“Itwasjustreally importantforustoworkonashow togetherthatwewerebothequally aspassionateabout,andobviously musiciswhatwe’rebothknownfor andit’ssomethingthatwe’vealways reallybondedover,soitwasjustlike anobrainer,really.”
EastEnders (BBC1)


Walfordresidentspast and presentgathertogethertosaytheir goodbyestoDot–Laurenarrivesin timetoreminiscewithRickybefore theceremony,Colin,MaryandDisa arewaitingatthechurch,andLofty putsinalatebutwelcomeappearance.Elsewhere,Alfie(ShaneRichie) planstoplayKat’sPrinceCharming inthepanto
Coronation Street (ITV)



Martha announcesshe’soff to Hulltoappearinanewplayandasks Kentoaccompanyher–untilshedis coversthetruthabouthisrelationshipwithWendy.Summerisforced to tell Mike andEsther aboutthe baby,whileTyroneplansasurprise wedding.


Emmerdale (ITV)

PaddysurprisesChaswitharomanticbreak,butBellecomesclean to Moiraabout what sheknows Kimchallenges Dawn andGab by to finda nan ny,and Mandyis shocked by the stateofVinny

����������� ��� ������ �� �������� O��� t� Inf�n�,J��i�� �n� P��m��� S�ho�l� ������ ���������� ������������� ���� �� ��� ���������� ����������� TV GUIDE THURSDAY,DECEMBER 8, 2022 | TELFORD JOURNAL 21
Editor’s weekend pick
Films for the weekend
Your guide to the soaps
Rochelle and MarvinHumes arethe hosts ofTheHitList 90sspecial
OrientExpress
Shane Richie
4,000 namesrememberedasTreeof Lightappealpasses£25kmilestone
By Daniel Morris
Thisisourfifthlistofnamesthat arebeingrememberedaspartofthis year’sTelfordTreeofLightAppeal.
RunbythefourRotaryClubsof Telford&District,theTreeofLight enablesthecommunitytoremember theirlovedonesandsupportlocal charitiesoverthefestiveperiod.
Inreturnforaminimum£5do nation,namesaredisplayedaround thetreeinTelfordShoppingCentre TheyarealsoprintedintheTelford Journalinbatcheseachweek.
So farinthisyear’scampaign, 1,600applicationshavebeenpro cessed, with 4,000 loved ones re membered anddonationsamount ingto£25,500
SevernHospiceandHopeHouse Children’s Hospices will receive themajorportion of fundsraised. Theremainder will be shared by ShropshireProstateCancerSupport Group,2nd WellingtonScouts,Tel fordAfterCareTeam,Telford&Wre kinYoungCarersServiceandJayne SargentFoundation
Amongthenamesremembered are:
MarionSans;WilliamSans;Bri an Sargent;Dennis Sargent;Eddie Sargent;Baden Savage;Veronica Seabrook;AndrewRichardSeager; MorningtonS.Seager;BrettSham bley;Gib Shambley;Kit Shambley; Richard&HazelShaw;HenryShep pard;FrankShingler;William(Bill) &MaryShore;AdrianSimmill;Terry Simmill;GeraldSimmonds;David& KarenSimmons;Kevin Simmons; TerrySimmons;Grace&BillSkelton; VeraSkitt;Eva&JackSmith;Patricia Smith;LiamSnailham
Eric &JeanSpicer;Loraine Sproson;Chris&AlfStanley;Dawn Stephan;JohnStevens;SidStevens; DorisStockin;FrankStockin;Ernest Storie;James(Jim)Sumnall;Donald Sutherland;AdaSykes;EddieSykes
JimTait;MavisTalbot;Bryan& NormaTaylor;Darkie&DaveTay lor;HarveyTaylor;LeslieJohnTay lor;WendyTelfer; Dennis &Joyce Thomas;HenriettaThompson;John Thompson;DoreenTinsley;William (Billy)Todd;GeorgeTomkinson;Vic Tonks; Victor Tonks; Ann(Lizzie) Traylor;Sue Trickett;Harry Turn bull;Lillian Turnbull;Julie Turner; Ray&KarenTurner;LawrieTurrell; NoraTwyford;SamuelTwyford;Ada Tyrer;TedTyrer
Elsie &Ted Vaughan; Price Vaughan;FrankVickers;IreneVick ers;JennieVines
Elsie Wade;RonaldWade; GeorgeWakeley;Margaret&Moses Wakeley;CliffWallace;MurielWal lace;ValerieWallace;BernieWalsh; Joan Walsh; ColinWalster;Shirley Walster; KennethWalters;Marion Walters;KimWardle;Alfred&Una Watkins;RebeccaNicoleWeaver.
Evelyn &NormanWedge;Dick &MaryWellings;Lewis Wheaver; DorothyWhite;GordonWhite;Ro salind Whitney; WilliamWhitney; Joyce Whittaker; DerekWild; Enid Wilkes;FredWilkes;TraceyWilkes; AliceWillard;FrankWillard;Richie Willard; DavidS.Williams;Edna Williams;EstelleWilliams;JohnWil
liams;MartinWilliams
Violet Williams;WilliamWil liams;Gilbert&MargaretWinwood; AndrewWood;BarbaraWood;En ochWood;JeanWood;LilianWood; CarlD.J.Woolley;TinaWootton;Wil liamThomas&MargaretWootton; FrancisJamesWorrall;JackWorrall; JohnWright;AlbertWyton
John Yarnold; AnnYates;Ann Yeo;ColinYorke;CraigYoung;Gay norYoung;MissyYoung;Rose&Vic Young.
EricAdams;KathAdams;Ellen Allan; HarryAllan;StuartAmbro se;EricAnderson; Gordon Archer; BettyArrowsmith; George Ar rowsmith;JamesArrowsmith;John Arrowsmith;MichaelAtkinson;So phieVictoriaAtkinson;Harry&Joan Avery;CarolAvis.
JessicaBailey;Julie Bakarania; Jackie Ball;Richard Barker; John Barnes;AlanBarnett;AndrewMi chael Barrass; TomBarrett;David Barsby;PaulBarsby;DennisRonald Bates;IvyMurielBates;RolandStan leyBates;MartinBauld;MaryBeach; TrevorBeal;Maud&LenBeard;Da vidBeardsmore; Herbert Becker; ChristopherBeckett;Sylvia&Peter Beddall;NigelBeddoes;SylviaBes sant;Raymond&EvelynBiddulph; StevenBiddulph.
WinifredBiddulph;Douglas Billinge;NormanBinnersley; Paul Binnersley;DaveBinsley;PaulAdri an Birch; Tony Blackham;George Blagbrough;RosealeenBlagbrough;

MalcolmBlair;KeithBlower;Edith Boden;JohnBoden;Lillian &John Boden;PeterBoden;RonBoden;Wil liam Boughey; JoeBradburn; John Bridge;MaudBridge;DerrickBrittle.
BarrieBroomhall;Maureen Broomhall; DerekBrown;Roy Brown; Sid Brown; Steven Brown; WendyBrown;Bert&OliveBullock; GeorgeBurn
AlfCallaghan;GarethCamp bell;Michael Campbell;Catherine Carey; JohnCarey;Michael Carey; GeorgeCarline;BettyCarr;Sophia Catt; Gwen &Bill Chapman; Mick Chapman;JohnRichardChilds;Enid Clarke;TimClews;JenniferCloete; Reginald Cloete;TraceyColes;Mi chelle Colley;Pat Colley;PaulCol ley; PearlColley; ElizabethCooke; VictorCooke;Diane&PeterCooper; BarryJohnCorbett;George&Hilda Corbett;AnnaCostin-Carey; Allan Critcher;NancyCrutchley;William Crutchley.
ClaudiaDavies; GillianDavies; LeonardDavies; Leslie &Myra Davies; NaomiDavies; Patrick Davies; PriscillaDavies; Rhys John Davies; Tom&Dorothy Davies; ValerieDavies;JohnDavis;Leonard Davis;DaphneDawson;SylviaDaw son;AliceDayus;BillDayus;Stan& NoraDeakin;Coulson&JeanDenton; Jeevan SinghDhanda; HazelDiss; Patricia Dixon;Roger Dodd; Irene Doley; Jenett Donaldson-Wood;Ian Drummond;ElizabethDuffin;Irvine Duffin;PeggyDunham.
RegEaton;EliseEdmunds;Wil liam Edmunds; EmilyEdwards; Graham Edwards; HarryEdwards; LouisaEdwards;MargaretEdwards; Thomas Edwards; TomEdwards; Alan Elcocks; Gerald &Olive Ellis; HildaEmery;JuneEmery;FredC.V.F Evans;NoraEvansneeBarnes;Ju dithEverill;RobertEwings;Lorraine Eynon
PeterFarrelly; Phyllis Farrelly; Andrew Faulkner;EnidFinn; Ray mondFinney;DarrenMFlack;Olive &RayFletcher;MichaelFlynn;Mar garetFollows;RoyFollows;Bernard JamesFord;DorothyFord;JohnFord; MaddieFord;SteveFord;GillianFos kett;PatriciaFoster;HarryandSyl viaFox;BernieFrost;GeofFrost
ChrisGallier;JayneGallier;John Garbett; Ronald Michael Garbett; HildaGardner;JackGarmson;Mavis Garmson;AlisonGater;AnnGater; Martin &Margaret Gaughan; Nev Gaut;AlbertGibbons;RoseElizabeth Gibbons;DorisGiles;MichaelGlaze; SusanGlaze;JeanetteGoldring;Jack &DoreenGraham;JanetGreenwood; Pearlene Greenwood;Barbara & JoeGriffiths;MichaelJohnGriffiths; DollyGroucott; Andrew Growcott; JosephGrowcott;BettyGulliver;Jack Gulliver;GeorgeBenjaminGumsley; EthelGwyther.
June Haden; PaulineHaines; LewisHall;MargaretHarman;Kath leen Harris;Olive Harris; Audrey Harrison;Jack&HazelHatton;Annie Hayward; KennethHayward;Ted
Hayward;MarjHealey;MaryHicks; HaroldHiggins;BarbaraHill;Charles Hill;EileenHinton;NeilHinton;Ben jaminHipkiss;ElsieHipkiss;Rupert &Ivy Hockenhull;AlfredHocking; LilianHocking;Jim Hodson;Kath Holding.
RayHolland;StuartHollins; Grace&JohnHolt; Ronald Hope; Lynn Houghton;Alistair Houlton; IntombizodwaHove;GavinHughes; Hazel&TerryHughes;RobHughes; Tom&BettyHughes;ChristineHum phreyson;Harry Humphreyson; MarionHumphreyson;NeilHunter HildaJackson;JacquelineJack son;VerityJackson;EvaJarvis;June Jarvis;PhilipJarvis; AddisonJohn; AlanJones;ArthurAlanJones;Clive Jones;DavidJones;ElizabethJones; EthelJones; Florence Jones; Gor donJones;JohnRobertJones;Kevin Jones;LindaJones;MargaretJones; MayJones; MichealLeslie(Mick) Jones; NancyJones; Nancy &Les Jones;RonJones;StanleyJones;Sean Jordan;IreneJukes;JackJukes
KuzmaKaczmarczyk; Pawlina Kaczmarczyk; PeterKaroly; Par kashoKaur; Gertrude &Kenneth Kearton;AliceKelly;ReivleyKenne dy;BarryKerr;NormanKirton;John Knight;LeslieKnott;AngelaKrneta; MasonKrneta;MilanKrneta;Ashok Kumar.
GordonLamb;GwenLamb;Gwen Lampard; Joseph Lampard; Danny Lane;LisaLane;SusanLatham;Irene andDennisLavender;BillLaw;Peter Lawrie;PeterLecouteur;AlanLee; BerylLee;TonyLeigh;JoanLesueur; BerylLewis;Frank&AudreyLew is;GordonLewis;NancyLewis;Ray Lewis;Robert(Bob)Lewis;ViLewis; Arthur Lowe;Matilda &Frederick Lowe;RoyLowe;AllanLuter;Marga retLuter;SimonLyttle
MaiMacKenzie;Craig Mansell; LilyMarkland; Andrew Martin; James Martin; Mick Masefield; CharlesMason;LilyMason;Fred Massey;SandraMatthews;JeanMay bin;JimMaybin;KatrinaMccormick; WilliamMcGladdery;Hazel McK ee;Sam McKee; Claire Mellinship; MargeryMerrington;WilliamMer rington;Barbara&GeorgeMiddle; George&VioletMiddle;GarethMi nards; WilliamMoir; BettyMoore; GordonMoore;FredMorgan;Isabel Morgan;LuckyMorrell;AlbertMor ris;Cis&DoraMorris;MurielMorris; NicolaMorris;JudyMortimer;Sally AnnMorton.
CeciliaNewbrook;KennethNew brook;Robert&MargaretNiblock; DerrickNicholas;MargaretNicholl; Robert James& MargaretNicholl; DerekNipe;JoanNoel;KennyNow bath
SusanO’Hara; Elizabeth &Ar thur Oakes; Lesley &JeffO’Cal laghan;RoyOrton.
BrianPaddock;EvelynPad dock;JeanPaddock;KathleenPad dock;Kevin Parkes;JuneParkins; John Parry; CecilParton; Peter Parton;Roxyanna Parton;Gerald CharlesRobertPass; DorisPeake; FrederickPeake;Eva &Bill Perry; Kathleen Joan Perry; BrianPheby; MarionPhillips;PeterPhillips;John Pierpoint;Phyllis&CecilPierpoint; PaulRaymondPitcher
Musiciansentertained atthelaunchoftheTreeofLightinTelfordShopping Centre
FEATURE TELFORDJOURNAL | THURSDAY, DECEMBER 8, 2022 22
Caribbeanislandgem’s deep blue skiesand sapphire seas
Liftingthe venomousspikes, I carefullycutalongthestripedpur pleskinofthelionfish.Whenalive, thesesharp spikes candeliver a stingcausingextremepainandeven paralysis.Socatchingthisdelicacyis noeasyfeat
They’realsonotoriouslydifficult tofind,hidingcamouflagedincoral andimpossibletocatchinnets.But hereontheDutchCaribbeanIsland ofCuraçaothesestrikingseacreaturesareaninvasivespecies,nega tivelyimpactingnativefishcolonies andreefs surroundingthe island since2009 afterbeing introduced intoFlorida’swater.Cullingefforts meanhuntingthesefishisnowlegal –andnecessary.
Local chef,Helmi Smeulders, originally from TheNetherlands, liftsahugewoodenspearintothe air, with asharp metalend anda spring,pullingitbackandsendingit forwardtoshowhowshecatchesli onfishwhilediving.Theysellfor$10
 By Lauren Taylor
By Lauren Taylor
eachwhole,andfourtimesthatfillet ed,sofordiversabletofindthem,it’s lucrative.Plus,thefishisdelicious pan-friedordeepfriedinbatter,she says.Todaythough,
Just37milesfromtheVenezuelancoastline, betweenAruba and Bonaire–makingupwhat’sknown astheABCislands–Curaçao,with itsdiverse cultural history is the location of thenew SandalsRoyal Curaçao,whichopenedinJune.


A25-minutedrivefromthecap ital Willemstad,the all-inclusive, couples-onlyresortboastsanopenairentrancelobby,leadingoutontoa viewofthedoubleinfinitypool–the firstinthebrand’s17-strongcollec tionacrosstheCaribbean,pool-side gazebos,palmtreesandocean.

Ahitforhoneymooners,there’sa realairofexclusivity,withoutahint ofpretentiousness.Whileontheho
tel’sbeach,crystalclearshallowwa tergentlylapsthesandandguests read bookson floatingplatoons, leavingonlyperhapstoordera‘dirty banana’cocktail(rum,coffeeliquor, bananaandcream)ortheworldfamousBlueCuraçaoliqueur
Withunlimitedalacartedining, thereareeightrestaurantstoeatat andeightpoolstoswimin,including someguestscanstepstraightinto fromtheirprivateterrace.
Ifyouwantevenmorespace,15 milessouthofCuraçao,istheuninhabitedislandofKleinCuraçao.As we glide into thebrightest of turquoise wateron acatamaran tour with Island Routes (islandroutes. com,$138USD/£114pp)beforediv ingintoswimtothelongstretchof emptysand,it’spostcard-perfect
Turtlespottingiscommonhere andreefsofferdiversplentytosee, butalow,flatislandisapparently difficulttospotfromthebridgeofa ship,andasaresultahuge,rusting
wreckofanshipfromthe1980sand adilapidatedweather-beatenlighthouse standlikeeerie beaconson theotherwiseempty,smallsliceof Caribbeanparadise.
Humanhistoryonthisconstitu entcountrywithintheKingdomof theNetherlandscanbetracedback in picturesque world heritage site, Willemstad.HereIfindstrikingcor alstonebuildingsinEuropeanneoclassical styleadorned in vibrant Caribbeancolours.Agovernoronce orderedallhomestobepaintedin bright colours becausethe white buildingsweregivinghim aheadache,our guide Maja AtalitaVer vuurtsays.
It transpiredheowned theisland’s biggestpaint company, but thecolourfulhousesstuckandthese dayswallsofthecitycomewithalot ofbeautifulstreetarttoo
The17thcenturyoldtowncen trePunda with thepicturesque Handelskade–acolourfulstretchof
waterfrontbuildingsgivingserious Amsterdamvibes–andthe19thcen turyOtrobanda(meaning“theother side”inDutch)areseparatedbythe watersofSaintAnnaBayanditsfa mousfloatingpontoonbridge.Andif you’recrossingwhenaboatneedsto pass,itsimplyswingsopenintothe channel,sopedestriansbetterhold ontight.
MuseumKuraHulanda,located at thecity-centre harbour, docu mentstheisland’sdevastatinghis toryofslavetradingfrom1660sto therevoltof1795famouslyledby nationalheroTula,whoDannyGloverportrayedinthe2013filmbythe samename
Andthatclassicliqueurthatfea turesinmanyholidaycocktailsand hasmadethisislandfamous? It’s namedafter thedried peel of the bitter orange laraha,acitrusfruit grownhere.ButIprefertothinkit’s areferencetothesapphireseasand deeplyblueskies.
Christmas film sets to visit
Newresearchhasrevealedthe iconic Christmasmovie locations wherefanscanactuallygoandvisit PhotographyexpertsatParrot Print.comhavefoundfilmingloca tionsfromclassicChristmas films wherevisitorscanwanderaround andexplore.Hereare some iconic filminglocationstogetinthefestive spirit:
Shere,Surrey–TheHoliday Fans of this Christmasclassic willwanttovisitIris’scottage.Un fortunatelyhercosyhomewasaset builtfor filming.However, visitors canexplorethe chocolate-box villagewhereAmandaspendsthefestiveseason St Luke’s Mews, Notting Hill LoveActually Fanscanvisittheiconicscene

whereMarkexpresses his loveto Julietonherdoorstepwithaseries of handwrittensigns.The pretty streetisStLuke’sMewsinNotting Hill,London–andthepinkhome number27–hasbecomeatourist hotspot.
671Lincoln Avenue,Winnetka,Illinois–HomeAlone2
ThehomeoftheMcCallistersisa veryimpressivered-brickhomethat attractsfansfromallovertheworld Andtheneighbourhoodisdecorated withlotsoflightsforthefestivesea son.
TheIce Rink at Rockefeller Center,NYC–Elf
Themajorityoffilmingforthis festivefavouritetookplaceinNew YorkCity–andoneofthemostfestive things to do is go skatingon
theicerinkattheRockefellerCen tre,whereBuddyandJoviegoona Christmassydateand sharetheir firstkissontheice
3159 W11thSt, Cleveland, Ohio–AChristmasStory
Amuseumdedicated to this comedyfilmhassomeiconicprops as well as behind-the-scenes photosandagiftshop.Theiconichome of RalphieParkerisopenall year round.
Oakville, Canada –The Santa Clause
TheSantaClausewasfilmedall around Oakville–Ontario’s larg esttown.ThehomeofScottCalvin is locatedat17ChisholmStreet OakvillehostsanannualSantaClaus parade,whichexploressomeofthe iconiclocationsfromthefilm.
The 17thcentury town of Pundawithitscolourfulbuildings
The double infinitypool at SandalsRoyal Curacao
Cooking course– LaurenTaylor
SandalsRoyalCuracaoresort
TRAVEL THURSDAY,DECEMBER 8, 2022 | TELFORDJOURNAL 23
Shere, Surrey,setting for The Holiday







































Aerials Gardening Plastering Plumbing Property Maintenance Roofing Driveways &Patios Solar Power Blinds Double Glazing Services Personal Window Specialists Carpet Cleaning Carpentry Decorating Electrical Is your roof leaking? Specialists in: •Re-roofing •Tiling •Slating •Flat Roofs •Gutters &Fascias •OAP Discount •FREE Quotes We will beat any written quote TELFORD ROOFING &GUTTERING 01952 271370 •07791 190642 15% discount with this advert Landline: 01952 324300 Free: 08005353596 Mob: 07735 559 134 www.jpricecontractors.com Now Offering Insurance Back Gaurantees JPrice Roofing Ltd BEFORE AFTER NOTJUSTROOFS! Check our Website •Part ‘P’ registered •Warranty available •Out of hours service available •Small jobs •Fuse board upgrades •Full and part re wires Call Bill for afree quote 07871926721 www.wdsaunders-electrical.co.uk Friendly and reliable service ELECSA APPROVED www.electriciansintelford.com Call Bill for Free Estimate Call Ryan on 07733 778 960 Shropshire maintenance services Installation and maintenance of: •Showers •Bathrooms •Kitchens and Tiling •Power flushing •Heating systems •Landlord certificates from £55+VAT •Boiler installs from £1300 And all your plumbing needs Over 20 years experience All building work undertaken MILLS BUILDERS NO JOB TOOSMALL •GUARANTEEDWORK• FREE QUOTES Telford 01952 614421 Mobile 07533 656914 •Home Extensions •Bathrooms •WoodFlooring •Kitchen Installations •Fencing •Tiling • Plastering •Plumbing •FlatRoofs •Window Fitting Want to save money on your energy bills? 01902 932385 www.nealenergysolutions.com MCS and HIES accredited Solar Experts WINDOW REPAIRS Sealed units, hinges, handles and total replacements Call Lion Home Improvements: 01952 796927 07771 415 628 Now manufacturers of PERFECT FIT BLINDS Available in ahuge range of fabric colours and designs No drilling! No screwing! Child safe Easilyremovable forcleaning Call Phil on 01952 240 222 •email sales@telford-blinds.co.uk •www.telford-blinds.co.uk •Verticals •Rollers •Wooden Venetian Blinds •Faux Wood Blinds •VenetianBlinds •Vision Blinds •Remote Control Roller Blinds Local FamilyRun Business We are now doing pleated bifold doors Jeff&Kath Professional Decorating Couple “Excellence is doing thejob rightwhen no one is looking” Friendly,meticulousservice Greatprices on all painting and papering All paintand preparation includedinprice Free no obligation written quote Tel: 01952426378 07811 240336 Free quotes: 07973 848 438 /0800 0340 344 CONSERVATORYROOF LEAKING? Call us today,before it gets worse! •Misty units •Broken locks •Door repairs •Conservatory leaks &repairs LOCAL RELIABLE SERVICE 20 YEARS EXPERIENCE ALL WORK GUARANTEED SCOTTS WINDOWAND DOORREPAIRS Paul Fraser Carpentry Tel: 01952 525063 (night) Mobile: 07866 377945 (day) Full Carpentry Service l Doorssupplied &fitted l Full maintenanceservice l Lock replacements l Repairs to uPVC windows &doors, reglazes l 30 years experience Contact Paul Professional PLASTERING Service •Plaster repairs •Coving •Damaged walls &ceilings repaired/ overskimmed •Small plastering jobs •Semi retired Over35yearsexperience Call Nigel foraFREE quote 07979724506 •Patios•Driveways•Fencing •Tarmacing•Brickwork•Repairs •Cleaning&Sealing•Resin •Gravelling•Landscaping •Turfing •IndianStone •Flagging•Fascias•Soffits •Guttering 01952 898753 / 07450 937834 info@shropshiredrivewaysandpatiosltd.co.uk www.shropshiredrivewaysandpatiosltd.co.uk AllWork Undertaken /FullyInsured Double glazing giving you Double you MISTY WINDOWS? LET THE SPECIALISTS TAKE CARE OF IT Windows andDoors, Double glazing Installations &repairs including leaks, squeaks and locks Call Mathesonand Brown for more information more 07539 216 615 Freephone 0800 956 2453 Pardy’s Carpet Cleaning: Get in touch today! T: 01630 642878 M:07870 770426 email:pardy. gary1@yahoo.com www.pardyscarpetcleaning.com Painting & Decorating Over 35 Years Experience •All Aspects •Re-lets •Mod’s Call Harry: 07497 500340 Suppliers and Installers -CompositeDoors -Aluminium Bi-folds -Aluminium Bi-folds -Plastic Windows &Doors -Plastic Windows &Doors -Glass Repairs -Window /Door Locks -Residential Installer 01952541119 07545396661 Town and CountryShropshire Email: Townandcountryshropshire@yahoo.com JAMES:07729233709 01743724877 js-gardendesign@outlook.com Fencing, Clean patios & decking, Leaf Clearance, Wisteria, Apple &Pear Winter pruning trees &shrubs, garden clearance, Weeding, Plan &replantor createnew flower beds, Mulching around trees shrubs &perennials TERRYBROADHURST Painting&Decorating City&GuildsQualified Interior&ExteriorFullyInsured FREEQUOTES Clean&ReliableService Telephone01952610681 Mobile07742453541 42StaffordStreet,StGeorges,Telford ShotsDIYSOS ALL YOUR PROPERTY MAINTENANCE •Bathrooms •Kitchens •Guttering •Roof Repairs •Supply +Fit Tv Aerials Most DIY jobs catered for NOJOBTOOBIGORSMALL • CALL FOR AFREE QUOTE Tel Ken Tinsley: 01952 404805 •Mobile: 07944 109250 email:shots321@gmail.com Call: 01902 410268 /07850 330251 TV Link Ltd AERIAL &TV SPECIALISTS We repair allkinds of TVs, Plasmas, LCD, 8out of 10 problems fixed on the spot FREE QUOTES ANYAREA DIGITALAERIALS SKYDIGITAL CCTV CAMERAS FITTED TV’s Wall Mounted andset up HD TV’s From £99-ManySizes -Delivered We nowrepair Laptopsand Mobile phones 271016424 TED LCD 7 ANY TV REPAIRS FREE QUOTES 56A High Road, Willenhall WV12 4JQ www.tvlinkltd.co.uk TV’sFrom £129 -ManySizes -Delivered We all kinds of TVs, Plasmas, LED FOCUS OF THE WEEK We offerafriendlyand professional service to all our customer’s,our aimisfor 100% customer satisfaction We takeprideinproviding an excellentservice to all our customer’s,that’swhy we ask our them to leave feedback on theproject’s we have completed. Their reviewwilltell you how experienced we areand how we preformed on their project. Youcan viewphotos of the project’s we have completed and customer reviews on ourwebsite We cover the wholeofShropshireoffering allofyourdriveway and landscapingneeds including: Resin, Tarmac, Block paving,slabs, concrete, car parks etc Landscaping walls, astroturf, turf, fencingetc Pleasecall forfurther information or to discuss booking a quote on 01952 897607 or emailtrentlandscapes@gmail.com or youcan visit our websitetofind outmoreand look at our images and reviews www.trentlandscapes.co.uk TRENT LANDSCAPES We started our family business in 2006. Many of our customer’shave used our service’srepeatedly over the years. To advertisein Local Specialists and reach thousands of potentialcustomerscall 01952 288813 andask for your local branch
ARROWSMITH

Edna
Of Cord ingl ey Wa y, Donnington, Telford.
Passed away peacefully at the Princess Royal Hospital on November 26,2022,aged 79 years.
Loving Wife of Graham and a much loved Sister and Aunt.
Funeral Service to be held at Telford Crematorium on Thursday,December 15, 2022 at 10.30am.
Family flowers only please, donations if desired for the Severn Hospice for which purpose acollection boxwillbeprovided at the Crematorium.

All inquiries
LINNING
Martha Of Dawley
Sadly passed awayatThe UplandsNursing Home on November 25, 2022, aged 74 years.
Beloved Wife of the late Ian, devoted Mum andGranny who will be deeply missed by all.

Funeral Service 2.30pm Thursday,December 15 at St Johns Church, Lawley
Family flowers only by request, but if desired, donations which will be dividedbetweenthe Severn Hospice andThe Uplands Nursing Home would be appreciated.
All inquiries to
MACERA
Italia Maria (Maria)
Passed away peacefully at the Princess Royal Hospital on November25, aged 92 years.
Beloved Wife of Michele (Mike),adored and much loved Mum of Tina, Carol, John, Tony and Aldo, Mother-in-law of Stephanie, Tanya, Lorraine, Martin and the late David.
PreciousNan of Ashley, Hayley, Ben,Liam, Alex, Cole,Paige, Max andElla, Great-Nan of Isaac, Mason, Lewie, Hudson, Conorand Harper

Maria will be greatly missed and neverforgotten by all her Family and Friends.
‘A bright shininglight has gone out of our lives’.
Funeral Service 1.45pm Tuesday,December13, at St Patricks Roman Catholic Church, Wellington.

Please weara splash of colour
OSMAN
Ali
Of Wellington Gasworks.
Fell asleep peacefully on November 22, 2022.
Aged 27 years.
Beautiful Son of Clare and Ali.
Loving Brother to Charlotte and Jack.

Loving Partner to Kerry.
Daddy to McKenzie, Alfieand Sienna.

Uncle to Ameera, Rahman, Raheem,Kaleem, Baby Shahzeer,Aliyah and Jack Ali Osman. Brother-in-law to Shahzeer and Chick.
Funeral Service to take place at Wellington Cemeteryon Tuesday,December 13 at 10.30am.



Floral tributes welcome. Donationsifdesired to be put towards amemorial for Ali
Asplash of navy can be worn.
Inquiries to
TomEvans
Vera Evans
Patricia
Julie Fowler
Michael Gorman
Elisabeth Green
Anne Griffiths
Tony Hancox
ValHughes
Peter Humphreys
Ray Johnson
Carl Kendalll
Robin Kinvig
David Lea
Brian Lewis
Jack Matthews
GaryMitchell
Shirley Moore
Edith Morris
Julia Mortimer
Carole Mott
Irene
Of Pool View CaravanPark, Buildwas.
Passed away withher Daughters by her side on November 19, 2022.
Aged 83 years.
LovingWifeofthe late Reg, much loved Mum to Susan, Karen and Dawn. Aproud Gran and Great-Gran.
Funeral Service 2.45pm Monday,December 12, 2022 at Emstrey Crematorium, Shrewsbury.
Donations, if desired, would be appreciated for The Midlands Air Ambulance.
All inquiries to
JONES
Joan
Formerly of Wellington.
Passed away at Briarfields Re sidential Home on November 24, 2022, aged 92 years.


Devoted Wife of the late Noel, Mum, Grandma and Great-Grandma.
She will be sadly missed.

Funeral Service. 2.45pm, Thursday,December 15 at Emstrey Crematorium, Shrewsbury.




Flowers welcome or if desi red, do nati ons to Briarfields Residential Home would be appreciated.
All inquiries to
Family flowers only by request, donations if desired for Hope House would be appreciated.
Inquiries to
Passed
PROUDLEY
Aged 79 years.
Devoted Husband of Christine.

Loving Father of Steve and Linda.
Much loved Grandfather of Sarah, Michael and Tom.
Funeral Service to be held at Telford Crematorium on Monday,December 19 at 11.30am.
Family flowers only please.
Donations if desired for Cancer Research UK for which purpose acollection boxwillbeprovided at the Crematorium.

All welcome.
Inquiries to
Malcolm Peel
Phillip Ralphs
Natasha Raynes
Clive Reynolds
Brian Richie
Marian Sayer
Gregg Scott
John Seddon
Daphne Smewing
Carolyn Smith
Brenda Turner
Gillian Wheal
Ron Williams
Deaths Funeral Services Acknowledgements FENN’S MEADOW GREEN BURIALS ECO/GREEN BURIALS &INTERMENT /SCATTERING OF ASHES Tel01948 880 002 www.shropshiregreenburials.co.uk
DAVIES
Christopher John
away peacefully at The Princess Royal Hospital on November 26, 2022.
Barbara Arthur Trevor Bishop Don Boyling
Glenys Breeze
Amy Chapman
Brian Clayton Josephine Cook
‘Anne’ Evans
Family ANNOUNCEMENTS OURTEAMARE HERE TO HELP…01952 242424 With whenyou it matters most www.clivepughfuneraldirectors.co.uk Clive Pugh Funeral Directors 95 AbbeyForegate Shrewsbury 01743 244644 WILSON MEMORIALS LTD UnitJ3 Sandford Industrial Park, Sandford,NrWhitchurch SY13 2AN 01948841493 www.wilsonmemorials.co.uk with many yearsofexperience Family Owned Monumental Masons 133 Longden Coleham, Shrewsbury SY3 7DN 87WhitchurchRd, Shrewsbury SY14EE Tel01743 344646 www.pughsfuneraldirectors.com THURSDAY,DECEMBER 8, 2022 | TELFORD JOURNAL 25 FAMILY ANNOUNCEMENTS
WANTED EXPERIENCED GARDENER












Items For Sale Bikes Items Wanted Car Boot Sales In Your Garden Elderly &Disabled Caravans Wanted Caravans Wanted REGULAR GARDEN MA NTENANCE WEEKLY, FORTNIGHTLY&MONTHLY Tree felling, pruning, shaping, fencing, driveways, slabbing, turfing, stump removal, hedge trimming, lawn mowing, Call Josh for afreequote 07825 588284 JCGardenServices@yahoo.com www.jc-gardenservices.co.uk TREE SURGEON &LANDSCAPING Garden Services JC ACROSS 13.Fight (4-3-3) 14.Guard (7) 15.Yield (6) 16.Ravine (6) 17.Meant (7) 18.Drunk (5) 19.Tatters (4) 20.Cut off (5) 21.Intended (5) 22.Slice of bacon (6) 23.Nervous (5) 28.Frivolous (7) 30.Treatment (7) 33.Crooked (9) 36.Instructed (6) 38.Aside (5) 39.Due (5) 40.Go off (6) 42.Vapour (5) 43.Manages (7) 44.Steady (6) 46.Dance (4) 49.Pace (4) 51.Dislike (6) 53.Artist (7) 55.Blow (5) 59.More unruly (6) 60.Force (5) 61.Understood (5) 62.Keep (6) 63.Painting (5,4) 65.Jumped (7) 66.Refuge (7) 70.Walk (5) 71.Dog (6) 73.Apportion (5) 75.Attempt (5) 80.Excitement (4) 82.Section (5) 83.Deceives (5,2) 84.Warning (6) 85.Indian (6) 86.Mild (7) 87.Undecided (2,3,5) DOWN 1. Crumple (6) 2. All right (4,4) 3. Sure (5) 4. Sentimental (7) 5. Look (6) 6. Crockery item (5) 7. Marvel (6) 8. Dispute (7) 9. Amazing (10) 10.Anger (5) 11.Big attraction (4,4) 12.Haul (4) 24.Recreation (7) 25.Compartment (5) 26.Sibling (7) 27.Horse (7) 29.Courage (5) 31.Save (5) 32.Story (4) 34.Empty (6) 35.Index (4) 37.Seized (7) 41.Occupation (7) 45.Complains (6) 47.Soon (7) 48.Dominion (7) 50.Cheat (7) 52.Bad (4) 54.Alcove (5) 56.Country (5) 57.Left (4) 58.Sequence (5) 60.Quarrel (10) 64.Rhyme (8) 67.Curb (8) 68.Said (7) 69.Headgear (7) 72.Somewhat (6) 74.Scots girl (6) 76.Gives (6) 77.Saw (5) 78.Fish (5) 79.Bore (5) 81.Kind (4) Crossword S:ACROS 13 -all;ee-forFr 14 Lookout; 15 Return; 16 Canyon; 17 noted;De 18 ght;Ti 19 Rags; 20 Sever; 21 Aimed; 22 Rasher; 23 Jumpy; 28 Shallow; 30 rapy;The 33 Dishonest; 36 ught;Ta 38 Apart; 39 Owing; 40 Repair; 42 Steam; 43 Handles; 44 Stable; 46 Reel; 49 Step; 51 Hatred; 53 inter;Pa 55 nch;Pu 59 lder;Wi 60 Drive; 61 cit;Ta 62 Retain; 63 ife;llilSt 65 Started; 66 reat;Ret 70 amp;Tr 71 Setter; 73 Allot; 75 Essay; 80 Stir; 82 e;ecPi 83 kesTa in; 84 pache;5A;8Threat 86 t;Clemen 87 In two minds. rease;:1CDOWN ery2V well; ound;3B 4 Maudlin; lance;5G late;6P ;8erond7W Contest; taggering;9S 10 Wrath; 11 Star ;turn 12 Drag; 24 stime;Pa 25 Booth; 26 Brother; 27 Charger; 29 Heart; 31 Hoard; 32 Plot; 34 cant;Va 35 List; 37 Grasped; 41 rsuit;Pu 45 Bleats; 47 Shortly; 48 Mastery; 50 ister;Tw 52 Evil; 54 Niche; 56 China; 57 nt;We 58 Order; 60 Difference; 64 Limerick; 67 strain;Re 68 Uttered; 69 s;Bonnet 72 Rather; 74 Lassie; 76 ards;Aw 77 Spied; 78 Skate; 79 Stood; 81 pe.Ty CROSSWORD SAYCE’S OAKENGATES ALL FRIDGES,FREEZERS,FURNITURE, BEDS AND GARDEN ITEMS,ETC HOUSE CLEARANCES Saleable Items Collected Free Call Debbie on 01952 610337 or 07966 432751 HAVE YOU CHECKED your adver tisement today? We would respect fully remind advertisers that it is their responsibility to inform the publish ers of any mistakes or inaccuracies on the first day of publication. STAIRLIFTS RECONDITIONED STRAIGHT from £495* NEWSTRAIGHT from £1495* NEWCURVED from £3295* (Includesfitting&warranty) &Remove Stairlifts up to £500paid on Har,dicare, AgeUK, Acorn& Brooks (subjecttoage) FREEPHONE 0800 096 5499 WANTEDBYCOLLECTOR ENAMELSIGNS Old bottles, pot lids, printed stoneware, advertising items. Coins, medals, gold and silver items. Cash paid. Anything old and interestingconsidered 07980 469859 /01743 361786 BESTSATURDAY BOOTSALE 6amOnwards MovingbackonA454HiltonbetweenW’ton andBridgnorthbyWheelPubWV155NR 07890 267041 OLDER CARAVAN WANTED for project and makeover, any size, make or condition, happy to collect as long as it will tow, anything con sidered. Call 07903 093535. CARAVANSCAMPERS WANTED from £200 -£6000, anycondition considered,repairs carried out, willcollect, Call Alan Bridgnorth 07496172252 BELLS CHRISTMAS DECANTERS (24), complete set, with boxes, all A1 condition, £725. 01939 260716. LOGS FOR SALE,Bridgnorth, good barn dried logs. £60 per builders bag. Telephone 01746 766117.
aspects of gardening includingweeding, no lawns or hedges.Small but well stoked garden.Amateur or professional welcome. 1-2hrs per week. Craven arms area Write Box No. P22297 (WS), Shropshire
Street, Wolverhampton, WV1 1ES ★★★★★★★★★★★★★★★★★★★★ ★★★★★★★★★★★★★★★★★★★★ ★ ★ ★ ★ ★ ★ ★ ★ ★ ★ ★ ★ ★ ★ ★ ★ ★ ★ ★ ★ ★ ★ ★ ★ ★ ★ ★ ★ ★ ★ ★ ★ ★ ★ ★ ★ Any Age or Condition *CASH *WAITING* Immediate collection Call Bill on 07825 325 913 All Caravans Wanted 1 FAMILY 2 LEISURE TIME 3 HOME& SERVICES 01952244244 8.30am -5.30pmMon -Fri.ClosedSat/Sun and Bank Holidays Desktop,tablet& mobile bookanad.shropshirestar.co.uk Family 1 Leisure Time 2 Home &Services 3 Pets &Animals 4 Business &Farming 5 Property 6 Jobs 7 Motoring 8 Public Notices 9 Personal 10 Index PLACEYOUR ITEM FORFREE UP TO £250 Visit: bookanad. shropshirestar.co.uk Simply pressthe free advert icon Sorry, no pets,gunsorlivestock Private advertisersonly. TO ADVERTISETELEPHONE 01952244244 VISIT: BOOKANAD.SHROPSHIRESTAR.CO.UK Motoring Property Homes& Services Pets Family Jobs TELFORDJOURNAL | THURSDAY, DECEMBER 8, 2022 26
Preparedtodoall
Ltd,Newspapers Queen
NOTICE TO READERS
Please be aware that when purchasing apuppy there are somesimple guidelines you canfollow to ensure that you are not purchasing from a Puppy Farmer:
1. Try to ensure you visitthe puppy whilst it is still withits Mother.
2. Do not arrangetocollect a puppy from anyother location than that of the breeder.
3. Ensure that you are given any KC documentation,if pedigree WhilstMidland News Association publicationstake great care to avoidpublication of advertisements fromPuppy Farmers we cannotaccept any liability shouldreaders purchase from this kind of establishment.






for our websites, as well as covering stories as theyhappen on live blogs.






We arelooking forNCTJ-trained journalists, able to deliver accurate,entertaining copy to meetstrict deadlines. Afull, clean driving licence is required.

We will also consider NCTJ Diploma trained journalists who are working towardstheir NQJ.


This is abrilliantopportunity to join our newsroom, covering a diverse, vibrantand busypatch.
Benefitsinclude acompetitive salary, 25 days’annual holidayand the chance to develop your career at Britain’slargest independent regional news company.
If youare interestedinthis role, please send acopyofyour CV and covering letter forthe attention of theeditor-in-chief, MartinWrightbyDecember 19, to:hr@claverleygroup.co.uk

Farm Machinery Public Notices Plumbing &Heating Removals House Clearances Cars Over £1500 Classic Cars Cars Under £1500 Scrap Vehicles Pets Corner Guns &Dogs Aerials Property Maintenance Roofing Driveways &Patios Blinds Appliance Repairs Home Improvements Handyman Services Full Time General Accommodation To Let NEIL THE ODD JOB MAN for allthose jobs youHATE! BASED IN TELFORD Gardening Gutter cleaning &repairs Jet spraying Shed Re-Felting &Painting Call Neil for a FREE estimate 01952 272354 07588 897768 www neiltheoddjobman.co.uk ALL OTHER WORK CONSIDERED A1 AUTOBREAKERS J.M.S TOP PRICESPAID Payment on collection CARS-VANS-MOT FAILURES Skips Supplied FOC• Collection Service FERROUS &NON FERROUS METALS WANTED 01952 580736, 07931 996955 Licenced to take your endoflife vehicles Certificate of Destruction Issued T&C’sapply BRETTELLS specialise in House clearances. Free Appraisal. Probate and Insurance Valuations for solici tors. 01952 815 925 From tap washers to complete installations, Call 07772 106 270 (Based in Telford) Visit: www.aaaps.co.uk Credit cards accepted (T&CsApply) ALL TRADERS Claimyour FREE ADVERT Now! CallClaireSmith: 01902319661 claire.smith@expressandstar.co.uk AERIAL/SKY SPECIALIST ANY TV REPAIRS Digital Aerials Fitted Sky &TVWall Mounts Free Quotes. 7days 07850 330251 Topqualityverticalblinds, Roller blinds,Senses roller blinds,Venetian blinds, Wooden blinds,Faux Wood blinds,Visionblinds Available in ahuge range of fabric colours and designs NOWMANUFACTURERS OF PERFECTFIT BLINDS We arenow doingpleated bifold doors 01952 240 222 email sales@telford-blinds.co.uk www.telford-blinds.co.uk Paul Myler Transport 07729 697 353 paulmylertransport@hotmail.co.uk ABACK TO BASICS REMOVAL Value,reliable, Almost anything, almost anywhere NOTICE TO ADVERTISERS Advertisers must ensure that they meet all necessary legal require ments for owning and using guns.
LEGAL /PUBLIC NOTICES For convenience you may email any advertising requirements. Please send emailto publicnotices@ mnamedia.co.uk or call Suzanne Cooper on 01902 319695. Please include aname and contact number for confirmation of receipt. OUR ADVERTISERS are reminded that it is an offence under the Scrap Metal Dealers Act 2013 to buy scrap cars/metal for cash. ADVERTISERS ARE REMINDED that the Business Advertisements (Disclosure) Order of 1977 requires that advertisements must clearly differentiate between Private and Trade. NOTICE TO READERS It is an offence under the Accom modation Agencies Act 1953, for an agency to charge afee simply for the registration of your require ments and/or supplying particulars of premises to let. 01743 630105 •01952 928107 • Block Paving • Walls &Patios • Tarmac • Landscaping • Turfing • All types of groundworks • Cleaning, Sealing &Repairs www.drivebuildpaving.co.uk BROSELEY FLATS TO RENT Birnbeck Housing Association have ashort open waiting list for 2bedroom flats to rent Contact: 02082018484 SPECIALISTS IN ALL TYPES OF ROOFING &EXTERIOR PAINT WORK •Firestone Rubber Cover •FlatRoofs •Leaking Roofs •UPVC Fascias, Soffits &Cladding•Chimney Repairs Maintenance 01952899148 07867842091 FREE quotes Jones’sProperty Fully Registered Company Aname you can trust. We are aFamily run business 25% off with this advert! office@jonesspropertymaintenance.co.uk www.jonesspropertymaintenance.co.uk WANTED Cars, Vans &4x4s Scrap Damage,Faulty Vehicles &MoT failures Min. £130 to £5,000 (T&C Applies) INSTANTPAYMENT TooGood to Scrap Minimum Paid £200 to £5,000 TopPrices Paid for Quality Used Vehicles ANY AREA -ANY TIME 01743 620618 Free ring back service 07506 110313 salop vehicleremovals@gmail.com 1hour collection service Unwanted Vehicles Removed FREE CHEAP CARSFOR SALE Vehicle RecoveryService from £30 VW GOLF TDI PLUS S 5-dr hatchback, 55 reg., black with matching interior, very good condition, very economical, MOT. £1,795 ono 07836 204450. deolsuk@hotmail.co.uk CLASSIC CAR Iamretired enthusiast and looking for aclassic car, running or not, Triumph, Ford, Jaguar, Mercedes SL, Porsche, TR6, Stag, MG etc or anything interesting considered. Condition not important. Please Telephone Ron 07733 784015. 51-53 QUEEN STREET, WOLVERHAMPTON WV11ES TEL: 01902313131 SENIOR JOURNALISTS Love news?Lovetalkingtopeople? Want to makea difference? Britain’slargest independentregional news companyislookingto recruit senior reporters. The Midland News Association, publisher of the Express &Star and Shropshire Star,islooking forpeople with experience and enthusiasm to join its team. We areparticularly looking for: •SpecialistCrime and Courts Correspondent– Achance to work one of Britain’snewsiestregions, offering an understanding and insightinto the challenges facing police as well as covering major court cases. •SeniorNewsCorrespondents –Reporterswith relish who will bring in hardnewsstoriesand human interest features, bringing in frontpageleads and substantial onlinetrafficand able to take on lively and interesting background news features.
areroles forambitious, dedicatedand enthusiastic journalists with aproventrack record
These
ti
contentfor
of our
news features
newspapers,
news arti
As amul
-mediajournalist,you mustbecomfortable producing
all
printand digital platforms–fromin-depth
forour
to breaking
cles
ASS ISTED NEUT ERING / SPAYING (DOGS) For more infor mation phone between 10am -6pm 07553
FLOORS2GO LAMINATE• SOLIDWOOD •CARPETS •VINYLS VISIT OUR SHOWROOM Trench Road, Telford, TF2 6PL 07307 377950 NowOpen --Huge Choice LaminateFlooring Engineered Flooring Best Prices WANTED Air Guns, Shot Guns, Antique Guns Etc, Vintage Animal Traps &Taxidermy 07968 624202 FORDSON DEXTER BONNET £40, front nose cone, £90 Tractor Roll Bar, £85. Telephone 07365 818314. ABSOLUTELY all Classic vehicles wanted from 1940 to 1994, any condition, cash paid. 07973 798488. GUTTER REPLACEMENT /Repairs, Exterior Painting, Jetwashing Fencing, Turfing, Garden Clearance &Gardening 07967 720740 KIA SPORTAGE GT LINE Kia Sportage GT line 2017 67 plate 1.7 diesel 6speed manual 68125 mile 1previous owner remainder of 7year warranty all the usual extras alloys sat nav parking sensors cruise control wheelchair hoist in rear £13,000 ono 07894 620717. FORD KA 1.3 52 reg., wine, 57,000 genuine miles, 12 months MOT, PAS, CD, excellent condition, drives superb. £895 ono 01743 440556 /07783 431565. CAVAPOOS AND CAVALIERS licensed breeder, 50 years 07867 530504. (Bridgnorth) 4 PETS & ANIMALS 5 BUSINESS 6 PROPERTY 7 JOBS 8 MOTORING 9 PUBLIC NOTICES LOOKING FORA CAR? FINDITWITHCLASSIFIEDS Search hundredsofquality newand used cars today! Visit: classifiedads.shropshirestar.co.uk THURSDAY,DECEMBER 8, 2022 | TELFORD JOURNAL 27
245566.
MG picksupthe pace
Is therea better value SUVonthe road than this plug-inhybrid?
It’s aserious question,and yes thereare some brilliantcandidates, butin termsofsheer valuefor money,HStakes some beating.
Price, well it speaks foritself and starts at just over £31k andstill comes with themarket leading or matching seven-yearwarrantyand features MG Pilot,araftofsafety measures usuallyseenasanoptional extra on rivalbrands.
TheHSisthe largestofthe SUVs coming in just above theequally stylishZS. Thereare twomodels, theExciteand theExclusive,driven here.MG’s firstplug-inhybrid, it combines a90kWelectricmotor with a1.5-litre turbocharged petrol engine.Thisdeliversacombined poweroutputof258PS andanelectric-onlyrange of 32 miles.


Thepower unit is matedwitha 10-speed auto transmission to deliver rapid pace,allowingittohit the 60mphmarkin6.9 seconds. Econo my is atheoretical 155.8mpg,but I foundittobequite thirstywhenthe electric rangewas exhausted,with an estimatedmid-40s mpg.
At just over £33k forthe range-topper,ithas thrown down thegauntlettomoreestablished andmuchmoreexpensive compet itors.
Theeye-catchingdesignfeatures theiconicMGbadge dominating the
BILLMcCARTHY
deep grille, flankedbyLED head lightclustersand largeair scoop.
Sitting on smart, 18-inchalloys, themuscular linesslope to therear wherethe twin tailpipes andan aluminiumlower bumper give it a sporty finish
Thelarge interior hasgood head andlegroom allround andthismod el hascomfortable electrically oper ated leatherseats giving thedriver acommandingviewofthe road.It features an arrayofsoft-touch fin ishtodashand sports seats, with fewerofthe harshersolid plastics Standard kitincludeskeyless entrywithpushbuttonstart,a10.1 inch colour touchscreen with Apple CarPlayand AndroidAutoand elec tric foldingand heated door mirrors and360-degreecamera.
Thereisalsoa leather finish to themulti-functionsteering wheel, whilethe centraltouchscreen info tainmentsystemcontrols satnav, DABradio/CD/auxand phonecon nectivity.
Thegoodies getbetterasyou move up therange andthisrange-topper adds frontand rear LEDsequential indicators,dual-zone climate control, ambientlightingand panoramic sunroofand electronicopeningtailgate.

Rear seat passengers arecatered fortoo with the recliningseats Therideiscomfortable while
handling isdecentapart from the occasional wallow on corners. The modeldeliversplentyofpacefor itssize, whileemissions of 43g/km make it cheaptotax
Thesizeofthe carismatched by thebootspace with an impressive 448litresofluggage space. Folding therearseats flat extendsthe total capacity to 1,375litres. There’salso adualheightboot floor.
Safety kitisimpressivewiththe MG Pilotset-upofferingsafetyaids, includingActive EmergencyBraking, Lane Assist,Adaptive Cruise Control, ForwardCollision Warn ing, BlindSpotDetection,LaneDepartureWarning System andRear CrossTrafficalert
FACTFILE
MG HS EXCLUSIVEPHEV
Price: £33.595
Mechanical: Combined 258PS 1,498cc, 4cyl petrol engine and electric motor driving front wheels via10-speedautogearbox


Maxspeed: 118mph
0-62mph: 6.9seconds
Combined mpg: 155.8
CO2emissions: 43g/km
Warranty: 7yrs/80,000 miles
Christmasmarkets to visitinanEV
ThebestChristmas marketsin England to visitifyou’redriving an elec tric carhavebeenrevealedinanew study.
Manchester Christmas Market topped therankingsofthe survey conducted by PeugeotUK, whichlookedat thenumberofpublicchargepointsthat were offeredwithinathree-mileradius of 14 of VisitEngland’smost-popular Christmas markets. They also looked at charging speedsavailable,and ac commodationwithfreechargingwas also scored
Theresearch also investigated how many of themarketscould be reached usingthe 225-mile rangeofthe Peugeot e-208from15ofthe most populated cities in theUK.

Alltop 10 Christmasmarkets– save forPadstow’s eventinCornwall– were accessible from at leastnineofthe UK’s most populatedcities. Manchester’sChristmas market came outon top, with 14 cities in theUKwithina 225-mileradius. It also hadthe highest number of charging stations, with 69 availablewithina three-mileradius. This included 16 rapid chargers offeringspeedsofover50kW.
Birmingham FrankfurtChristmas market came in second place, with Leedsplaced thirdwithits 62 charging stations –including 17 rapid units. The Yorkshirecitycould also be reached from 13 of theUK’smostpopulated cit ieswithinthe e-208’s225-milerange
JulieDavid,managingdirector, PeugeotUK, said:“Christmasmar ketsare apopular destination to visit during Novemberand December and Peugeot’slatestresearch hasrevealed themarketsand cities that best cater forelectricdrivers.
“Withmorethana million electric driversonUKroads today, things like distance andcharginginfrastructure will play an important role in determining wheredriversheadtothis Christmas.”

York topped thetablesinterms of EV-focusedaccommodation options, with 19 differenthotelsand B&Bs of fering free charging forcustomers

DATE // SELL YOUR CAR QUICK WITH A PIC! 01952244244 bookanad.shropshirestar.co.uk Only£9.99 6nights in print and online* *CheaperthanEbay/checked 2017.Privateadvertisersonly CHEAPER THAN* 3GREAT REASONSTOSELL YOUR CARWITHCLASSIFIED: 1. NO HIDDENCOSTS -the price yousee is theprice youpay 2. Over 680,000 potential buyers each week 3. CheaperthanEBAY!* MOTORING TELFORDJOURNAL | THURSDAY, DECEMBER 8, 2022 28
APeugeot wasusedinthe survey
Sittingvolleyballonthe up as TelfordEagles flyhigh
PAUL JENKINS paul.jenkins@mnamedia.co.uk
TelfordEaglessitting volleyball team is alive andkicking as thesport goes from strength to strength.
Theteamwas formed in 2018 when coachPaulTwitchell re turned from watching the Invictus Gamesin Australia, amulti-sport eventcreated by Prince Harry for wounded, injuredorsickarmed forces personnel.
He wasinspiredbythe inclusive nature of thesport andbrought it to thealready existing TelfordVol leyballClubwhere he trainedand played.
In England, sitting volleyball is playedbetween mixed-sexteams of disabled andnon-disabledplayers, with theemphasis on itsinclusive nature

Thehighest competitiveoutlet at themomentisthe Paralympics wherethe sportisplayedbetween same-sex teams of athletes with qualifying disabilities
On theinternational scene, Great Britainhas amen’s andwomen’s sitting volleyball team plus ateam that goes to theInvictusGames
TheEaglescompetedintheir firstnationalGrand Prix series in 2019 with Twitchellastheir coach, managerand captain.
He hasstepped down nowbut theclubcontinues andtrainsevery Wednesdaywiththe supportof coachesand players from Telford Volleyball Club’s standing teamand thecommitmentfroma fewofthe originalEaglesmembers
RichardLewis from TelfordVol leyballClubsaidthe sportgeneral ly is growingall thetimebut with publicity generatedbythe Invictus Games, thesitting versionisgoing from strength to strength
He said:“Sincelockdownwe
have seen amassive interest from theyounger generation wishingto participatein volleyball,including my ownson whowas committed to football at one pointbut joined the Telfordcluband nowlovesplaying thesport
“Over thelastyearinparticular
we have seen teenagers improve so much we have enteredsecondteams in both themen’s andladies’ senior league on topofour successful first teams.”
TheEaglestrain everyWednesdayatOak Tree Centre,Light moor Village(6.15-7.15pm) with
thesessionsofferingvolleyball accessible forall ages, abilities or disabilities
They welcome newcomersorexperiencedplayers andto find out more,gotothe TelfordVolleyball Facebook page or www.telford volleyballclub.weebly.com
Stretton in seventhheavenastheyreach thesummit
Church Stretton Town took ad vantageofleaders DawleyTown not playingtomovetothe topof theSalop LeisureLeague.
WhileDawley’s clashwith SAHA FC waspostponed,Stretton put seven past hosts MadeleySports, whomissedthe chance togo fifth in thePremier Division table.
ShaunDaviesmay have scored in the28thminutefor Madeley, butthatwas asgood as it gotfor them as bagged sevenoftheir own to take theirgoaltally to 62 in just 12 league gamesthisseason.
Jack Briscoe andHarry Morris each bagged abrace,whileJames Hill, AlexanderRyder andsubstitute Dean Richards were also on target
Hodnet sitinthird –six points behind Stretton,but likeDawley,
with twogames in hand.Their latest victorywas a5-1 success at WemTown,thanks in part to ahat-trick by Macauley Clifton Marcus Dillon andCameron Dour ishalsohit thenet
Fourth-placed Ludlow and fifth-placed MordaUnited were involved in ShropshireChallenge Cupaction, with Ryan Clarke scor ingfourofLudlow’s eightgoals in a huge victory.
Josh Bull,Harry Jones,Ryan Lewisand Stefan Varsi-Hirons were also on target,whileMorda couldnot respond.
While PreesUnited couldnot quitematch their14-0 triumph from thepreviousweek, they hit thegoaltrail once more to down St Martins 8-1.
Last week’s four-goalheroSam
uelFlory hadtosettlefor just abrace on this occasion –afeat matchedbyChris Owen
Theother Preesgoalscorerswere DannyBeirne, TomClive,Ollie Sumner andJacob Freely Eric Mensah andMartinMensah each notchedsecond-half doubles as Ercall ColtsEvolution sawoff GobowenCeltic5-1
AgoalfromMatthew Stuart andapenalty by JamiePortersaw Wrockwardine Wood edgeout Shrewsbury Up &Comers 2-1, with AblaySowe on target forthe county town team.
Just onematch took placeinDivision One, butitsaw Ercall Colts Revolution climbaplacethanks to a5-1 victoryat Shrewsbury Juniors Marc Wardle,Westley Weston,
Dillon Robb, DominicUdohand Alistair Heighway scored forErcall
Andinthe Division OneLeague Cup, BrownClee were 2-1win ners at bottom club Ercall Colts Rangers
Saturday’s fixtures (2pm kick-offs)
PremierDivision: Broseley v Church StrettonTown; Gobowen Celtic vWem Town;Hodnetv MadeleySports; PreesUnitedv Wrockwardine Wood;SAHA FC vMorda United;Shrewsbury Up &ComersvDawleyTown; Ercall ColtsEvolution vLudlow.
Division One: AFCBridgnorth DevelopmentvLlanymynech; BrownCleevShrewsburyJun iors; Wellington Amateurs vErcall ColtsRangers
Alportleave it late forathrilling victoryoverCity
Whitchurch Alport pulled off an extraordinarylatecomeback to take allthree pointsinaninegoal thriller againstWorcester City
Worcester, whoare struggling just outsidethe MidlandLeague PremierDivisionrelegation zone,tookthe lead through Dy lanHart andReiss Taylor-Ran dle. JamesRowland notched for Whitchurch before the break, as they enteredhalf-time losing 2-1.
Thevisitorsmadealightning fast starttothe second half as Hart scored againwithinamin utetomakeit3-1,beforeSam Yeardley pulled onebackfor Whitchurch just twominutes later. Then,justtwo minutes af terthatgoal, Whitchurch equalisedthrough Alex Hughes.
In what wasafrantic fixture, Taylor-Randlescoredhis seconddirectlyfromafree-kick to restoreWorcester’s lead, before thehosts edged thecontest Whitchurch hadtowaituntilthe 80th minutefor another equaliserwhenJordanEvans pulled them levelbeforeHughes notched hissecondofthe game in the90thminutetogivethe hosts adramatic5-4 lead.Joe Care wasgiven asecondyellow card in the95thminute, but they held on Elsewhereinthe league,anotherhigh-scoringaffairsaw Market DraytonTownlose 5-2toStudley
JamieHands andHarvey Lewisscoredthe goalsfor the hostsbut it wasnot enough as theleague’sbottomclubfellto their17thlossfrom18games
Meanwhile, Shifnal Town were held to agoallessdraw away at LichfieldCity. Kane Lewiscameclose forthe visitors, whileKeanu Cooper wasdenied by thecrossbar in atight contest
In MidlandLeagueDivision One, Shawbury United picked up acrucialwin with a1-0 victory away at Ingles
Despite theLeicestershire club complainingonsocialmediaabout theofficials, claim ingthe free-kickthatled tothe Shawbury goal was‘soft’and that they were denieda‘blatant penalty’,the Shropshire outfit returned home with allthree points
Elsewhereinthe league, AFC Bridgnorth threwawaya lead to lose 5-2athome to Hinckley
AKarlGriffithscornerwas turned into hisown netbya Hinckley defender aftersev en minutes to putBridgnorth ahead, butthe visitors turned on thestyle to take a4-1 advantage. Griffithsscoredasecondhalf consolation before the visitors addedanother,as Bridgnorth fell to defeat
Bottom club Haughmond also lost 6-3toOJM BlackCountry, whileinthe NorthWest Counties League Division One South, EllesmereRangers lost 3-1toleagueleaders Stockport Town
TelfordSitting Volleyball Clubhas been buoyedbythe Invictus Games
SPORT THURSDAY,DECEMBER 8, 2022 | TELFORDJOURNAL 29
Roll of honour
Junior Boy: MatthewMorris
Junior Girl: MillieParry
YouthMale: Oliver Parton
YouthFemale: Lauren Kenvyn
GerryGladwellAward(wicketkeeping): Charlie Ward
Disability Awards
S9sPlayer: OliHarrison
D40Player: Shaun Rigby
Disability Champion of the Year: Dave Hassall
CoachingAwards
YoungCoach of theYear: Josh Anders
Coachofthe Year: Naomi Payne
Outstanding Contribution, Services to Coaching: Andrew Leggatt
Outstanding Contribution, Services to Coaching Development: Rod Jones


Schools Awards
Primary School of the Year: OldParkPrimary
SecondarySchoolofthe Year: HLC
PrimarySchoolTeacher of theYear: Andy Parton,Old Park

Primary
SecondarySchoolTeacher of theYear: SophieJones,HLC
SEND School of theYear: Southall School,Dawley
SEND Teacherofthe Year: Rob Davies,SouthallSchool–Women& Girls’ Awards

Women’sCricket Champion: NaomiPayne
Women’sUpand Coming Club of theYear: ChelmarshCC
Women’sTrailblazers: Shel tonCC
Women’sClub of theYear: WemCC
Women’sTeamofthe Year: Frankton CC
Girls’ Club of theYear: WellingtonCC Shropshire Star Awards

AllStars Champion Club: AlveleyCC
DynamosClub: WilleyCC
InspireAward: Whittington WitchesCC
Beyond theBoundaryHub: Sutton HillHub on theHill Beyond theBoundaryCom munity Champion: MarvynJoseph Development Club of the Year: Sentinel CC
ECBGrassrootsAwards
ConnectingCommunities: WellingtonCC
Inspired to Play: Matt Earley
Rising Star: GriffDavies
Game Changer: Chloe Green
UnsungHero: TimBarber
Growingthe Game: Neil and
Acelebration of

Theachievementsof clubs, players, schools, communitiesand volunteersincricket across Shropshirewerecele bratedatthe Board’s annual Presentation Evening.
Morethan250 people were at theSovereignSuite at Shrewsbury Town’s Montogmery Waters Mead ow forthe event– the firsttimeit hasbeenheldatthe venue.
BoardChair Adrian Collins paid tributetoall whoreceivedawards on theevening
He said:“It wasgreat to seeso many people in attendance on the nightcelebrating theachievements of people acrossthe cricket community in Shropshire
“There issomuchgoodworkbeingdonetopromote andgrowthe game,and it is brilliantthatweget thechancetohighlightthe achievementsofsomanydifferent people whohelpmakecricket thegreat game it is in thecounty.”
Anew sectionwas introduced to theevening to recognise theimpor tanceofthe growinglinkthe Board andschools in thecounty.
Sixawardsweresplit between Primary, Secondaryand SEND (SpecialEducational Needs) schools.
ThePrimary Teacherofthe Year awardwenttoAndyPartonfrom Old Park PrimarySchoolinTelford CommunityCoach RyanLockley said:“Andy couldn’t have made us feel more comfortableeachtimewe enteredthe school,his welcoming stylewas extremely reassuring
“His excellentknowledge and willingness to help wasshownin theway they supported with deliveryinschool.
“His dedication wasextended furtherasthe school enteredboth theKS1&2 Chance to Shineprima ry school competitions
“Heisasuperstar at dishingout flyers forlocal club links,promoting summer events at Malinsleefor our communityprojectsand is also very engaging forthe children of Old Park Primary.
“Heisanabsoluteinspiration to cricket in thecommunity and school.”
Old Park School were named Chance to ShinePrimary School of theYear

AlbrightonCC, Allscott Heath CC,Alveley CC,Bomere Heath CC,BridgnorthCC, Chelmarsh CC,Claverley CC,Condover CC, Cound CC,Ellesmere CC,Forton CC,FranktonCC, Knockin &Kin nerley CC,LilleshallCC, Ludlow CC,Madeley CC,Newport CC, Oswestry CC,Pontesbury CC, QuattCC, Sentinel CC,Shelton CC,Shifnal CC,Shrewsbury CC, St Georges CC,WellingtonCC, WemCC, WhitchurchCC, Woore CC,WorfieldCC.
Lockleysaid: “Thisschoolset the standard extremely high with great attainmentand 100per cent effort from allstudents within theclasses that we delivered to
“The staffengagementwas also fantastic, theirwillingness to get stuckinand supportcontributed to thehugesuccess.”
Hadley Learning Communityhad doublecause forcelebration after landingThe SecondarySchoolof theYearaward whileSophieJones collected TheSecondarySchool Teacherofthe Year accolade
Southall School in Dawley also landed awinningdouble, picking up TheSENDSchoolofthe Year award
whileRob Davies took TheSEND Teacherofthe Year award.
Theeveningalsocelebratedanothergreat yearfor Women& Girls’ cricket in Shropshire with more teams gettinginvolvedatall levels of thegame.
Womenand GirlsRecreational Cricket OfficerKatie Rushtonsaid: “There hasbeenplentyofaction throughoutthe year.
“The autumn andwintersaw the
Indoor leaguesreturnat Wrekin Collegepreceded by theadditional league at Shrewsbury School Cricket Centre
“Spring sawtastersessionsat AllscottHeath CC as they look to re-engageand encouragenew la dies to join theirset up
“SoftballFestivals were in full swingwithlastyear’strailblazers NewportCCand Albrighton CC continuing to thrive
“The indoor season also proved successfulfor ourhardball teams with more involved this year than ever before
“Following this severalnew teamsjoinedsummer hardball ac tivity, includingthe Pontesbury ladies findingtheir feet in themid week league andKnockin &Kin nerley striding into thenew Shropshire8sLeagueFinals Dayduring their firstseasons of hardball.”
SPORT TELFORDJOURNAL | THURSDAY, DECEMBER 8, 2022 30
Jennie Good –Safehands Award
Disability Champion Dave HassallVolunteer AwardwinnerKeithYapp
Lifetime Achiever Dave Ralphs
Manny andJuliefromHub on theHillPictures: BrianClarke/Kidz in Focus
WemCCare allsmilesafter winning theWomen’s Club of theYear award
VolunteerGroundsManage
Sally Owen Lifetime Achiever: Dave Ralphs Safehands Award: Jennnie Good
ment of theYear: Keith Yapp Hall of Fame: EveJones Clubmarkclubs
Andy Parton from OldPark Primary
agolden summer
Pace aceDillon presents awards to thefab four
Four Shropshirecricket coaches were honoured on thenightand were presented with theirawards by Worcestershire andShropshire fast bowler Dillon Pennington

TheYoung Coachofthe Year awardwenttoJoshAndersfrom Shrewsbury CC.
Ed Ashlin, whoissecretary of the ShropshireCricket CoachesAssociation, said:“Josh hasbeeninstru mental in thedevelopment of both of youngpeopleand more recently the ladies at theirclub.

“Hehas demonstrated excellent commitment to theclub.”
TheCoach of theYearaward went to NaomiPayne from Oswestry CC Ashlinsaid: “The nomination for Naomiwas impressive,there is no doubtshe hasgonethe extra mile to extend thereach of cricket in and around theirclub.”
TheOutstanding Contribution Services to Coaching Awardwentto Andrew LeggattfromOswestryCC.
Ashlinsaid: “Andrewhas had ahugeimpactonjunior cricketat theirclubfor over 20 years. With outhis dedication,the club would nothavethe junior sectionthatit continuestoproduce.”
TheOutstanding Services to CoachDevelopmentaward went to RodJones

Ed said:“Rodhas hadahugeim pact on coaching andcoach develop ment within Shropshire over along period of time,” said Ashlin
“Hewas one of theearly ECB ‘tu tors’and hasworkedextensivelyon ECBcertificatedcourses, enabling coachestopassthrough andhave apositive impact in the fieldwith theirclubs andschools.”
Furber appeals fornew players
An appeal to find more disabili ty cricketers in Shropshire was made during theevening
Eveleads theway into Hall of Fame
TheCricket ShropshireHallof Fame waslaunchedatthe annual PresentationEvening–withCen tralSparksand Birmingham Phoe nixstarEve Jones the firstcricket er to be inducted Shewas presentedwithaframed copy of thecitationwhich will hang on thewallatboard’s officesas part of theHallofFame.
Cricket Shropshire Lead Of ficerSteve Reesesaid: “Wehave arecordofproducingtop quality cricketersinShropshire, andwe decideditwas time to startrecog nising theirachievements through theHallofFame.
“Eve wasanobvious choice to be the firstasshe hasbeenatrailblaz er sinceshe wasayoungster and hasbeenagreat ambassadorfor Shropshire.”
Jones started hercricket jour neyatWhitchurchand wasone of the firstplayers on theShropshire Girls’ AgeGroup pathway. She

made herfull Shropshiredebut in 2008 againstNorthamptonshire andtop scored with ahalfcentu ry.Overthe next four yearsshe became establishedinthe side and wasthe leading runscorerinboth 2010 and2011.

From 2012 shemovedupa level to Staffordshirefor four years, leadingthe runscoring charts therein threesuccessiveseasons
Hernextmovewas to Lancashire whereshe wasamember of theside whichwon theCountyChampionship andTwenty20Cup doublein 2017.In2018she became captain and2019led them to second in the County Championship.
Sheplayedinthe Women’sSu perLeaguefor both Loughborough Lightningand then Lancashire Thunderbeforebecoming oneof the firstplayers to sign aregion al professional contract with West Midlands Cricketin2020.
That sawher switch to play for
Warwickshire, CentralSparksand Birmingham Phoenixin thenewly createdHundred
Shewas namedasCentral Sparksskipper in 2020 andina stellarcampaignin2021, shewas thethird topscorerinthe Rachel HeyhoeFlint Trophy in thecountry, andled therun scoringcharts in theCharlotte Edwards Cup.
In theinaugural Hundredfor Birmingham Phoenixshe was fourth in therun scoringchartsfor thewhole tournament –including the overseas stars.
Thoseperformancessaw herrat ed as the first-ever PCAWomen’s OverallDomestic MVP, andthen votedas thePCA Playerofthe Year by herpeers
Sheearnedacontract forthe MelbourneRenegades in theWom en’s BigBashLeaguefor 2021/22 andthenselection as theEngland Acaptain fortheir tour of Australia.
It came from coachGraham Furber as he highlightedthe successes of the2022season before presentingthe Disability Awards sectionofthe evening.

He said:“ArecentSCB au ditindicated that clubsdo have players in thecountywho could be considered forselection
“Welookforward to working with TylerIbbotsonasour first dedicatedDisability Officerand thenew Disability Hubclubs like St Georges,Shelton andWel lingtonindeveloping disability cricket in thecountyand hopefully findingsome morecounty standard players of both sexes to take thesquadsforward.
“Pleasebeassured that this is not‘Mickey Mouse’cricket –we areoften playingsides containingplayers whoplaySaturday cricket fortheir clubs, andeven in PremierLeagues throughout thecountry.Pleaseget in touch with us, we do need yourhelp!”
Thereare twodisability County squads. TheS9s play in crdiball cricketwithaminimum of nine players-a-sidewith30over gamesand theD40 which playsconventional 11-a-side cricket with 40-over games.
SPORT THURSDAY,DECEMBER 8, 2022 | TELFORD JOURNAL 31
TheGrowing theGameaward recipientswereSally andNeilOwen
MembersfromShelton CricketClubwith theWomen’s Trailblazers awardRepresentativesfromWilleyCricketClubwith their Dynamos Club award
CentralSparks star Eve Jones
Chloe Green –GameChanger
S9saward
winner OliHarrison
WE AREGETTING BETTER –WILKIN
Hornetsleave it late to snatch win
AFCTelford United are taking stridesinthe rightdirection despite anotherawaydefeatat Bradford Park Avenue on Monday.

TheBucks have not won agame away from home formorethantwo years, andthe 1-0defeathas made theposition in theNationalLeague Northevenmoreperilous–being 11 points adrift of 20th-placed Buxton Wilkin’s side went into thegame buoyed by their firstleaguewin un derthe bossonSaturdaywhenthey beat Banbury2-1,and they putin agoodshowinginYorkshiredespite thedefeat.
He said:“We really felt therewas an opportunitytobuild on what we didonSaturday, andwhenyou don’t, andyou lose by an oddmo ment in thegameitisdisappoint ing. Ifeelthatweare getting clos er to wherewewanttobe, clearly thereare stillstrides to make
“Butinthe firsthalf, we were ex cellent, so it is akickinthe teeth, buttheykeptgoing andforcedis sues

“Itisdisappointingwehavenot takensomethingout of thegame.
“I thoughtwewereworth at least adraw, andweshouldreallyhave wonthe game if we wouldhavetak en ourchances
“Wecreated lots of chancesin that firsthalfand some good half chances.

“Welookedreallycomfortable in thegame-wewerethe dominant side in the firsthalf.
“Wepassedthe ball really well, andIthink it wasthe best 45 min utes of football we have played since Ihavebeenatthe club.”
Tigerslose five gamesinarow
Twomoredefeats at theweekendsaw TelfordTigers’ losing streak extended to five matches.
ThereigningNIHLNational League champions were beat en 6-3atBasingstoke Bisonon Saturday andthenagain by the same scorelinetoSheffieldSteel dogs at TelfordIce Rink on Sun day.

AndheadcoachTom Watkins wantstosee hissidetighten up particularly on home ice
“Itwas anothertough night forusasa team,” he said.“You won’twin many gamesgivingup sixgoals at home
“Defensively,weweren’t good enough.Wesimplycan’t defend at themoment,nomatterwhat we do andeven when weget pos itives or momentum goingour way, we kick ourselves in the backside by continuallymaking thesameerrors.
“Thisisabig challengefor us to overcome as ateamand these arethe timesyou need thefans behind you.It’seasytosupport awinningteambut it’s when a team is struggling you seethe peoplewho really care
“Rightnow we have to em bracethe challengeas ateam andas afan base.”
Tigers have hadabad habit of conceding firstingames this season andthiscontinued in both matches.

They look to endtheir losing runatHullSeahawksonSatur day(5.30pm)and at home to MK LightningonSunday(6pm)
Longtonin

Counties OneMidlandsWest(North) thanks to alatepenalty from BenLewis Hornetstookanearly lead thanks to abreak by DanRobinsonfrom halfway.Hewas finallytackled just shortofthe tryline, butHornets retained possession andspreadthe ball to theleftfor Nathan Decalmer to go over in thecorner.
Longtonreduced thedeficitto5-3
with apenalty,but Telfordextend ed theirleadoncemorewhenthey counter-attacked from open space andJackHowse burstthrough tacklestotouch down andmakeit 10-3

Longton’s pack then gained a measureofcontroltoturnthe matcharoundbyscoring twoun converted tries, taking a13-10 lead into half-time Hornets levelled thescoreswith
apenalty by Lewison53minutes, only forLongton to counter-attack andscore their thirdtry –leaving Hornetstrailing 18-13.
This wasquickly reduced with a second successful penaltybyLewis Hornetscontinued to step up the pressure on Longton, forcinger rors, andthenon78minutes came thewinningkickbyLewis –alongrangeeffortfromwideonthe right that sailed throughthe posts.

Lawley Square,LawleyVillage,Telford,Shropshire.TF3 5BZ | 01952 324476 FRESHCHICKENCOOKEDDAILY11.00amto11.00pmIncludingBankHolidays&Weekends.EatIn,TakeawayandDelivery.MinDeliverySpend£15withinTelford FORFASTDELIVERYORDERAThttps://Lawleychicken-cottage.com/Menu/6892/chicken-cottage-telford MILKSHAKES 9FLAVOURS£3.25, TUTTIFRUTTI£3.50 6PIECE BOXDEAL 6PIECECHICKEN,4REGULAR FRIES,1.5LBOTTLE £13.99 KIDSCHICKEN FILLETBURGER MEAL£3.50 SMLFRIES, SMLDRINK&SAUCE PERIPERIHALF GRILLED CHICKENMEAL CHIPSANDDRINK (CHOICEOFRICE,POTATOES) £7.99 3MUSKETEERSSEASONALOFFER (MEALFOR3)3PCSBREADED CHICKEN,3CHICKENFILLET BURGER,3REGULARFRIES, 1.5LTRDRINKBOTTLE £16.99 MEGACOTTAGE FRIEDBOX 6PIECECHICKEN,2BREADED FILLETBURGERS,4SPICEY BREADEDWINGS,4STRIPS, REGPOPPERS,2SIDES,6FRIES £28.99 NEW INFERNO WHEN YOUORDER ON OURAPP ORDER DIRECT WWW.CHICKENCOTTAGE.COM INF 5S MEAL INFERNO BU INFERNOBITES MEAL £6.49EACH MEAL BLAZING FOR ALIMITED TIME ONLY sport Cricketers celebrate successfrom agolden summer –inside PublishedbyMidland News Association Ltd, 51-53QueenStreet,WolverhamptonWV1
Registered at the PO as anewspaper NEWSPAPERS SUPPORT RECYCLING Therecycled papercontent of UK newspapersin 2021 was65.7% Pricewhen sold £1.20 Thursday, December 8, 2022
1ES.
KevinWilkinbelieves
ollie.westbury@mnamedia.co.uk
OLLIEWESTBURY
TelfordHornetssurge forward duringtheir dramatic victoryoverLongton on Saturday
Picture: John Cutts
TelfordHornets climbedabove
rugbyunion’s
97 71 35 21 54 949 49

























































 WithRob Smith
WithRob Smith






























































































































































































































































































































 By Lauren Taylor
By Lauren Taylor





















































































